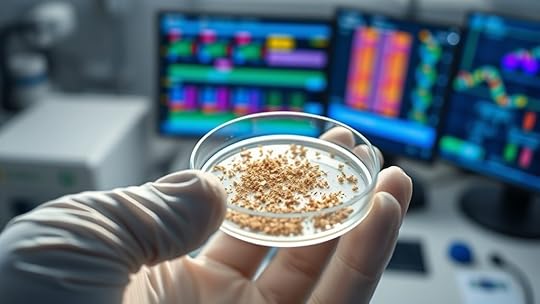

Michelle Nelson-Schmidt's Blog, page 32
August 23, 2025
Satellite Swarm Tracking of Migratory Thunderbird Patterns
Satellite swarm technology allows you to monitor thunderbird migration patterns with incredible detail by tracking their movements across long distances and uncovering behaviors previously hidden. This real-time data shows route changes influenced by climate and environmental pressures, helping you identify critical stopover sites and threats. As you explore further, you’ll discover how these advancements improve conservation efforts and address current challenges, opening new paths for understanding and protecting these majestic birds.
Key TakeawaysSatellite swarm technology enables real-time, detailed tracking of thunderbird migration routes over vast distances.It reveals unexpected route variations influenced by environmental changes and climate impacts.Tracking data helps identify critical stopover sites and feeding grounds for targeted conservation efforts.Ethical and regulatory standards ensure minimal disturbance and responsible use of migration data.Advancements improve long-term monitoring, enhancing understanding of migratory behaviors and habitat use.The Role of Satellite Swarms in Avian Migration Studies
Satellite swarms have revolutionized how researchers track and understand avian migration. They enable detailed observation of bird movements over vast distances, revealing migration routes and behaviors previously hidden. These swarms facilitate aerial communication among individual birds, allowing them to coordinate their movements efficiently during long journeys. By analyzing swarm coordination, scientists gain insights into how birds maintain group cohesion and adapt to environmental changes. Satellite technology provides real-time data, enhancing our understanding of migration timing and routes. This approach also helps identify critical stopover sites and potential threats. Overall, satellite swarms serve as a powerful tool, offering a extensive view of avian migration dynamics and improving conservation efforts. Your research benefits from this innovative integration of aerial communication and swarm coordination.
Technological Advancements in Tracking Migratory Birds
Advances in satellite connectivity now allow for real-time tracking of migratory birds with greater accuracy. At the same time, miniaturized tracking devices make it possible to attach sensors without hindering bird movement. These innovations are transforming how you study and understand migratory patterns across vast distances.
Enhanced Satellite ConnectivityRecent technological advancements have markedly improved satellite connectivity, allowing researchers to track migratory birds with unprecedented accuracy. A sophisticated satellite constellation now provides continuous, reliable data transmission, ensuring real-time updates on bird movements. These interconnected satellites reduce data gaps and enhance coverage over remote and vast areas, which was previously challenging. With more robust connectivity, you can access high-resolution tracking information instantly, enabling detailed analysis of migration patterns. The improved data transmission capabilities also minimize delays and data loss, making long-distance tracking more precise. As a result, you gain a clearer understanding of migratory behaviors, timing, and routes. This leap in satellite connectivity is transforming how you observe and study migratory species, unlock new possibilities for conservation and ecological research.
Miniaturized Tracking DevicesThanks to ongoing technological innovations, tracking migratory birds has become more precise and less invasive. Miniaturized transmitters now allow you to attach tracking devices that are lightweight and unobtrusive, minimizing impact on the birds’ natural behavior. These advancements in bird tracking technology enable you to gather detailed data without hindering flight or daily activities. The small size of modern transmitters means you can monitor even tiny species, like the Thunderbird, over long distances with minimal discomfort. As a result, you gain clearer insights into migration routes, stopover sites, and seasonal patterns. These innovations also improve data accuracy and device longevity, making long-term studies more feasible. Overall, miniaturized transmitters revolutionize how you study bird migration, combining precision with conservation-friendly methods.
Insights Gained From Real-Time Migration Data
Real-time migration data reveals how thunderbirds adjust their routes in response to weather and environmental changes. This information helps you understand the variability in their paths and identify critical stopover sites. It also offers new insights into their breeding grounds, highlighting key areas for conservation efforts.
Migration Route VariabilityBy analyzing live migration data from satellite swarms, researchers have uncovered unexpected variations in the routes that migratory thunderbirds take each year. These changes are often influenced by climate change, which alters traditional breeding and stopover sites, forcing birds to adapt quickly. Additionally, predatory threats such as expanding predator populations or new hunting grounds can cause thunderbirds to deviate from familiar pathways for safety. You might observe that birds avoid certain areas or shift migration timing altogether. This route variability highlights how environmental pressures impact migration strategies, making their journeys less predictable. Understanding these patterns helps researchers identify emerging threats and develop better conservation plans. It also demonstrates the resilience and adaptability of thunderbirds in the face of rapidly changing ecosystems.
Breeding Ground InsightsAnalyzing live migration data from satellite swarms provides crucial insights into the conditions and factors influencing thunderbirds at their breeding grounds. You can identify critical habitats that support nesting and rearing, emphasizing the importance of habitat preservation. The data reveals preferred landscape features, such as mature forests and open wetlands, which are essential for successful breeding. Additionally, genetic analysis of collected samples helps determine population diversity and adaptability, guiding conservation efforts. By understanding which areas foster healthy breeding and how genetic traits vary across populations, you can prioritize protection zones and habitat management. This real-time information enables targeted interventions to maintain healthy breeding environments, ensuring the long-term survival of thunderbirds. Ultimately, combining migration patterns with habitat preservation and genetic insights strengthens conservation strategies.
Conservation Strategies Enhanced by Satellite Monitoring
Satellite monitoring has revolutionized conservation efforts for migratory thunderbirds by providing precise, up-to-date data on their movements and habitat use. With this technology, you can observe avian behavior in real time, identifying critical stopover sites and feeding grounds that need protection. This detailed information helps prioritize habitat preservation, ensuring thunderbirds have safe routes and breeding areas throughout their migration. By tracking their patterns, you can detect threats like habitat loss or human encroachment early, enabling targeted interventions. Satellite data also supports adaptive management strategies, allowing you to adjust conservation plans as migration patterns shift. Ultimately, this technology empowers you to implement more effective, science-based conservation strategies that secure the future of thunderbird populations.
Challenges and Limitations of Satellite Swarm Technology
Despite the significant benefits of satellite swarm technology for tracking migratory thunderbirds, it faces several challenges that limit its effectiveness. Data transmission can be unreliable in remote areas, causing gaps in tracking data when signals weaken or are blocked by terrain or weather. Maintaining a consistent power supply is another hurdle, as the small size of tracking devices limits battery capacity. Frequent recharging or battery replacement isn’t feasible for many migrating birds, risking data loss or device failure. Additionally, energy consumption for constant data transmission strains the device’s power, reducing operational duration. These limitations hinder long-term, continuous tracking and can compromise the accuracy of migratory pattern data. Overcoming these challenges is essential for improving the reliability and scope of satellite swarm technology in avian research.
Future Perspectives on Migratory Pattern Research
Advancements in satellite swarm technology promise to revolutionize how you study migratory thunderbirds, enabling more detailed and real-time tracking of their journeys. This progress opens new research avenues, allowing you to comprehend migration patterns with unprecedented accuracy and depth. However, future research must address ethical considerations, ensuring the protection of the thunderbirds’ welfare and habitat. You should also prioritize data privacy, safeguarding sensitive location data from misuse or malicious intent. As technology advances, establishing clear guidelines and regulations becomes essential to balance scientific progress with ethical responsibilities. By doing so, you ensure that migration research benefits both science and conservation efforts without compromising security or integrity. Ultimately, these developments will deepen your understanding of migratory behaviors while maintaining ethical standards.
Frequently Asked QuestionsHow Do Satellite Swarms Differentiate Between Individual Thunderbird Species?When you’re tracking migratory thunderbird species, satellite swarms use advanced signal processing to differentiate between them. By analyzing unique flight patterns, wingbeat frequencies, and vocalization signals, the system identifies species precisely. This species identification depends on processing the data collected, allowing you to distinguish between different thunderbird types effectively. The combination of signal analysis and pattern recognition ensures precise tracking without needing direct observation, making your monitoring more efficient.
What Environmental Factors Influence Thunderbird Migration Routes?You should consider that climate variability considerably influences thunderbird migration routes, as changing temperatures and weather patterns affect food availability and breeding grounds. Habitat fragmentation also plays a role, forcing these birds to alter their traditional paths to find suitable nesting sites and resources. By understanding these environmental factors, you can better predict migration patterns and support conservation efforts to protect their habitats from further disruption.
Can Satellite Data Predict Sudden Changes in Migratory Behavior?You might think satellite data can predict sudden changes in migration timing based on weather patterns, but it’s not entirely certain. While satellites track environmental cues, abrupt weather shifts like storms or temperature drops can cause unexpected migratory behavior. Continuous monitoring helps identify patterns, yet unpredictable weather still challenges accurate predictions. So, satellite data offers valuable insights, but it can’t fully forecast sudden migratory changes caused by rapid environmental shifts.
How Does Satellite Tracking Impact Thunderbird Natural Habitats?You might wonder how satellite tracking impacts thunderbird habitats. By providing precise satellite accuracy, you can monitor their environments closely, helping with habitat preservation efforts. This technology allows you to identify threats like deforestation or urban expansion early. As a result, you can implement targeted conservation strategies, ensuring these majestic birds retain healthy habitats and continue their migratory routes without disruption.
Are There Ethical Concerns Regarding Satellite Monitoring of Wildlife?Did you know that over 60% of people worry about privacy concerns with new tracking tech? When it comes to wildlife monitoring, ethical concerns like data security and privacy matter. You might wonder if tracking animals invades their natural behaviors or risks their safety. It’s vital to balance scientific benefits with protecting animal welfare and ensuring data is secure, so monitoring doesn’t become intrusive or compromise privacy—whether for animals or humans.
ConclusionAs you observe the skies, imagine a shimmering swarm of satellites weaving through clouds, capturing the thunderbird’s majestic flight across vast horizons. This technology unlocks secrets hidden in migratory patterns, guiding your efforts to protect these ancient travelers. With each data point, you gain a clearer picture of their journey, empowering you to preserve their path. Embrace this future, where science and nature soar together, ensuring the thunderbird’s legendary flight continues for generations to come.
August 21, 2025
3‑D Printing Fossil Fragments to Reconstruct Dragon Physiology
Using advanced 3-D printing, you can transform fossil fragments into detailed dragon skeletons, helping you explore their anatomy and movement. By capturing precise digital scans, you can create accurate replicas of bones, scales, and claws, even filling missing parts with artistic interpretation. This approach bridges science and mythology, offering insights into prehistoric ecosystems and biomechanics. If you keep exploring, you’ll discover how these models deepen our understanding of extinct creatures and their environments.
Key Takeaways3D printing enables precise, tangible replicas of fossil fragments for detailed analysis of dragon anatomy.Digital modeling of fossil features reveals muscle attachment sites, informing movement and biomechanics reconstructions.Incorporating anatomical insights from fossil analysis helps create accurate models of dragon physiology.Material innovations allow testing of structural strength and flexibility in reconstructed dragon skeletons.Combining fossil data with artistic interpretation bridges myth and science, enhancing understanding of dragon biomechanics.The Role of 3-D Printing in Paleontology
3-D printing has revolutionized paleontology by allowing researchers to create precise, tangible replicas of fossil fragments. This technology enables detailed examination without risking damage to original specimens. With insights from genetic engineering, scientists can better understand ancient DNA and reconstruct extinct species’ features. Additionally, 3-D printed fossils often carry mythical symbolism, connecting science with cultural stories about legendary creatures. These replicas help bridge the gap between myth and science, sparking public interest and inspiring new hypotheses. By providing accurate models, 3-D printing accelerates research, education, and conservation efforts. It allows for collaborative analysis across institutions and supports the development of innovative reconstructions. Overall, this technology transforms fossil study into a more accessible, detailed, and interdisciplinary pursuit.
Discovering and Analyzing Dragon Fossil Fragments
The use of advanced imaging and 3-D printing techniques has opened new avenues for discovering and analyzing fossil fragments believed to belong to ancient dragons. By examining fossil preservation, you can identify key features linked to dragon symbolism, such as scales or claws, enhancing your understanding of their physiology. These methods help distinguish genuine fossils from artifacts and reveal subtle details invisible to the naked eye. Visualizing fragments through digital models allows for precise analysis and better interpretation of fragmented remains. This process accelerates discoveries and deepens insights into dragon anatomy, bridging myth and science.
Discovery MethodsAnalytical FocusImaging scansFossil preservation quality3-D modelingIdentifying symbolic featuresField excavationsGeographic distribution of fragmentsComparative anatomyUnderstanding physiological traitsTechniques for Recreating Dragon Bones and Structures
Recreating dragon bones and structures involves a combination of digital modeling, material fabrication, and assembly techniques that bring fragmented fossils back to life. You start with detailed scans of fossil fragments, then use digital tools to reconstruct missing parts through artistic interpretation, guaranteeing anatomical accuracy. Material fabrication methods, such as 3D printing with durable resins, replicate the bone’s texture and strength. While genetic engineering isn’t directly involved in physical reconstruction, it offers insights into potential biological features, guiding accurate modeling. You can also incorporate creative elements to emphasize certain traits, blending science with artistic interpretation. Finally, precise assembly ensures the structures are stable and true to the imagined physiology, providing a realistic foundation for further study or display.
Challenges in Replicating Mythical Creature Anatomy
Creating accurate replicas of mythical creature anatomy presents unique challenges because these beings often lack real-world counterparts or complete fossil records. Achieving mythical realism requires blending scientific data with imaginative interpretation, making it difficult to guarantee that models look believable while remaining true to legend. You must navigate gaps in fossil evidence and fill in missing details without compromising fantasy accuracy. This balancing act can lead to inaccuracies that undermine the creature’s authenticity or mystical qualities. Additionally, aligning anatomical features with known biology while respecting mythological traits demands careful judgment. As a result, reproducing these complex beings tests both your technical skill and your ability to integrate scientific principles with creative storytelling, highlighting the intricate challenge of capturing the essence of mythical realism in physical form.
Insights Gained From 3-D Printed Dragon Models
3-D printed dragon models reveal detailed insights into their structure, allowing you to analyze how different parts fit and support each other. This helps you understand their physiology more accurately than ever before. By examining these models, you gain a clearer picture of how these mythical creatures might have moved and lived.
Structural Analysis BenefitsHow do 3-D printed dragon models enhance structural analysis? They allow you to study complex bone arrangements and joint mechanics with unprecedented detail. By using digital sculpting, you can refine models to accurately reflect fossil features, ensuring precise reconstructions. Material innovations further enable you to test different strengths and flexibilities, revealing how bones and tissues might have supported the creature’s movements. These models make it easier to identify structural weaknesses or adaptations, providing insight into biomechanics and load distribution. You can manipulate physical copies to observe how different forces impact the anatomy, which isn’t possible through digital scans alone. Overall, 3-D printing transforms theoretical data into tangible evidence, deepening your understanding of the dragon’s structural integrity and physical capabilities.
Enhanced Physiological UnderstandingBy examining physical dragon models produced through 3-D printing, you gain a deeper understanding of their physiological features that digital scans alone can’t provide. Handling these models reveals details about biological adaptations, such as muscle placement, joint flexibility, and respiratory structures. This hands-on approach allows you to visualize how different features supported their survival strategies and behaviors. Additionally, exploring these models helps clarify evolutionary pathways, showing how specific traits may have developed over time. You can assess how anatomical modifications enhanced functionality or adaptation to environments. This enhanced physiological understanding bridges the gap between fossils and living creatures, offering insights into the complex biological processes that shaped these legendary beings. Ultimately, 3-D printed models deepen your comprehension of ancient physiology and evolutionary history.
Exploring Movement and Behavior Through Reconstructed Skeletons
By examining reconstructed skeletons, you can gain valuable insights into joint mechanics that reveal how ancient creatures moved. Analyzing muscle attachment points helps you understand their behavior and capabilities. Together, these details bring fossilized animals back to life in a way that tells their story of movement.
Joint Mechanics InsightsReconstructed skeletons from 3-D printed fossil fragments allow scientists to analyze joint mechanics in ways that were previously impossible. By examining joint articulation, you can see how bones fit and move together, revealing potential ranges of motion. This insight helps determine how a dragon might have moved or perched. Ligament dynamics become clearer as you study how soft tissues would have supported joint stability, guiding your understanding of flexibility and strength. With precise models, you can simulate movement, testing different poses and behaviors. These analyses shed light on the creature’s agility and interaction with its environment, providing a detailed picture of its biomechanics. Ultimately, understanding joint mechanics through 3-D printed fossils offers a fresh perspective on how these ancient beings moved and behaved.
Muscle Attachment AnalysisHave you ever wondered how scientists determine muscle placement on fossilized bones? They use biomechanical modeling combined with detailed muscle attachment analysis to infer how muscles connected and functioned. By examining the texture, scars, and ridges on bones, you can identify probable attachment sites. This process helps reconstruct movement and behavior accurately.
Bone FeatureFunctionSignificanceRugose ridgesMuscle attachmentIndicates strong, active musclesScar patternsMuscle insertion pointsReveal muscle size and directionTuberositiesJoint leverageAssist in movement analysisThis table highlights how specific features guide muscle placement, allowing for precise biomechanical models to simulate dragon locomotion and behavior based on fossil evidence.
Implications for Understanding Prehistoric Ecosystems
The ability to 3-D print fossil fragments considerably enhances our understanding of prehistoric ecosystems by providing detailed, accessible models of ancient organisms and their environments. With accurate fossil dating, you can establish precise timelines for species interactions and environmental changes. These models enable thorough paleoenvironment analysis, helping you visualize habitat conditions and climate factors that shaped ecosystems. By examining reconstructed structures, you gain insights into predator-prey relationships, dietary habits, and ecological niches. This approach allows you to explore how different species coexisted and evolved over time, revealing ecosystem dynamics often hidden in fragmented fossils. Ultimately, 3-D printing deepens your comprehension of ancient biodiversity and environmental shifts, offering a clearer picture of how prehistoric worlds functioned and adapted.
Future Developments in 3-D Printing for Extinct Species
Advancements in 3-D printing technology are poised to revolutionize how you study extinct species, enabling more accurate and detailed reconstructions than ever before. Future developments may integrate genetic engineering, allowing you to recreate biological features at a molecular level, enhancing realism in fossil replicas. This progress could lead to dynamic models that move or even exhibit behaviors, deepening your understanding of ancient creatures. Additionally, as mythical symbolism often influences modern interpretations, future 3-D printing could incorporate cultural narratives, blending science with legend. You might see fossils transformed into vivid, lifelike representations, bridging scientific accuracy with mythic storytelling. These innovations promise to expand your ability to explore and visualize extinct species, making your research more immersive and impactful.
Ethical and Scientific Considerations in Recreating Legendary Creatures
Recreating legendary creatures through 3-D printing raises important ethical and scientific questions that you must consider carefully. Ethical dilemmas include respecting cultural significance, avoiding misinformation, and guaranteeing responsible use of technology. Scientific accuracy is vital to maintain credibility and avoid misleading interpretations of fossil evidence. You should also evaluate the potential impact on scientific integrity and public perception. Addressing these concerns helps prevent the misuse of 3-D printing for sensationalism or deception. Balancing innovation with responsibility ensures that recreations serve educational and research purposes ethically. Ultimately, your approach must prioritize transparency, authenticity, and respect for both scientific methods and cultural sensitivities. Carefully steering these considerations helps uphold the integrity of reconstructing legendary creatures responsibly.
Frequently Asked QuestionsHow Accurate Are 3-D Printed Dragon Models Compared to Original Fossils?You might wonder about fossil accuracy when comparing 3-D printed models to original fossils. The modeling precision depends on the quality of the scans and the data used; high-resolution scans can produce very accurate replicas. While 3-D printed dragons may not capture every tiny detail, they generally offer excellent fidelity for study and visualization. Overall, they serve as reliable tools, though some minor discrepancies can exist compared to the original fossils.
Can 3-D Printing Help Identify Soft Tissue Structures in Dragons?You can use 3D printing to assist with soft tissue visualization in dragons by applying advanced anatomical reconstruction techniques. While fossils primarily reveal bones, 3D printing helps create models that integrate soft tissue details inferred from related species and imaging data. This approach allows you to better understand the dragon’s anatomy, making soft tissue identification more accurate and providing a clearer picture of how these creatures might have looked and functioned.
What Software Tools Are Used for Designing Dragon Anatomy Models?Imagine a dragon’s form coming to life on your screen. You use digital sculpting software like ZBrush or Blender to craft detailed models, blending creativity with precision. These tools enable anatomical visualization, allowing you to design intricate muscle structures and skeletal frameworks. They help you visualize complex physiology, making your models more realistic. With this software, you transform your ideas into detailed, accurate representations of dragon anatomy for study or display.
How Do 3-D Printed Models Influence Public Understanding of Prehistoric Creatures?When you explore 3-D printed models of prehistoric creatures, you enhance educational engagement and help debunk myths. These tangible replicas make ancient life more accessible, allowing you to see details that photos or text can’t provide. As a result, you gain a clearer understanding of these creatures’ true physiology, fostering curiosity and critical thinking. 3-D printing therefore plays an essential role in making prehistoric science engaging and accurate for the public.
Are There Limitations to Recreating Coloration and Texture in 3-D Printed Fossils?Imagine capturing the vibrant hues of a living creature, yet facing limitations in color fidelity and texture replication. You find that recreating accurate coloration and surface details remains challenging, as 3-D printing often struggles with nuanced shades and intricate textures. While it offers remarkable structural insights, the technology’s constraints mean you may not achieve perfectly lifelike fossils, leaving some visual and tactile qualities absent or simplified in the final reproduction.
ConclusionBy diving into 3-D printing of dragon fossils, you’re revealing the secrets of creatures long thought mythical, bringing ancient legends to life with jaw-dropping detail. Imagine walking through a prehistoric world where dragons once soared, all thanks to cutting-edge tech. As you explore these reconstructions, you’ll realize you’re on the brink of a scientific revolution that could rewrite history itself—making the impossible undeniably real.
August 20, 2025
CRISPR Screens of Alleged Werewolf Hair Samples Explained
CRISPR screening of alleged werewolf hair samples involves analyzing the DNA to determine if they come from humans, animals, or something unusual. Scientists extract DNA carefully, then use CRISPR to identify specific genetic markers. This process can reveal whether the sample is typical or contains anomalies. However, challenges like contamination or degraded DNA can affect results. To understand how researchers interpret these complex tests and the importance of scientific rigor, keep exploring further.
Key TakeawaysCRISPR screens analyze genetic material in hair samples to identify unique DNA sequences linked to human, animal, or mythical origins.The process involves extracting DNA, then using guide RNA and Cas9 to target specific genetic markers.Results help determine if the hair’s DNA matches known species or contains anomalies suggestive of mythical creatures.Scientific validation requires rigorous controls to prevent contamination and ensure reliable, reproducible data.Findings inform whether alleged werewolf hair samples contain typical DNA or evidence of genetic modification or myth.The Basics of CRISPR Technology and Its Applications
CRISPR technology is a powerful tool that allows scientists to edit genes with remarkable precision. It’s revolutionized genetic research, making it possible to target specific DNA sequences easily. To understand its applications, it’s helpful to look at folklore origins like werewolf mythology, where transformation and genetic change are central themes. While folklore depicts werewolves as shape-shifting creatures, CRISPR offers real-world potential for gene editing, possibly enabling targeted modifications in DNA. This technology uses a guide RNA to locate specific genes and an enzyme called Cas9 to cut the DNA at precise points. Its applications range from medical treatments to agricultural improvements. Although it’s inspired by myths of transformation, CRISPR’s real power lies in its ability to precisely alter genetic material, opening new frontiers in science.
How Scientists Analyze Hair Samples Using Genetic Screening
You can start by extracting DNA from the hair samples using specialized techniques that maximize yield and purity. Then, scientists identify specific genetic markers to determine the sample’s origins or unique traits. Finally, they interpret the data through computational methods to draw meaningful conclusions about the sample’s genetic makeup.
DNA Extraction TechniquesTo analyze hair samples for genetic evidence, scientists first extract DNA using specialized techniques designed to maximize yield and purity. This process often begins with fiber analysis to identify the hair’s origin and assess its preservation state. Proper sample preservation guarantees the DNA remains intact during extraction. Here are the key steps:
Carefully clean the hair to remove surface contaminants.Use chemical or enzymatic methods to break down the hair’s keratin structure.Isolate the DNA through centrifugation or binding methods.Verify the quality and quantity of DNA before proceeding to genetic screening.These techniques help ensure that the DNA is suitable for subsequent analysis, enabling accurate genetic insights from even tiny or degraded hair samples.
Genetic Marker IdentificationOnce the DNA has been successfully extracted, scientists move on to identifying specific genetic markers that can reveal essential information about the hair sample’s origin and characteristics. These markers help determine whether the sample might relate to mythical creatures or folklore origins. By comparing genetic sequences, you can pinpoint unique traits or lineage clues. This process involves scanning for variations in DNA regions known to differ among species or populations.
Marker TypeWhat It RevealsMitochondrialMaternal lineage, ancient traitsY-ChromosomePaternal lineageMicrosatellitesIndividual identitySingle Nucleotide PolymorphismsSpecific genetic variationsStructural VariantsLarge DNA alterationsData Interpretation MethodsAfter identifying specific genetic markers, scientists analyze the data to interpret what these findings reveal about the hair sample’s origin and traits. This process helps distinguish between genuine evidence and myth debunking of cryptid folklore claims. To do this effectively, you:
Compare genetic sequences against known human and animal databases.Look for anomalies or markers that suggest hybrid or unknown species.Assess the likelihood of the sample belonging to mythic creatures versus common animals.Cross-reference genetic data with historical folklore to understand if stories might stem from real but misunderstood animals.This method allows scientists to move beyond myth debunking, providing scientific clarity about mysterious hair samples and whether they truly relate to cryptids or are simply misidentified ordinary animals.
Interpreting the Results: What Do the Data Reveal?
The data from the CRISPR screens provide compelling insights into the genetic makeup of the alleged werewolf hair samples. With an adequate sample size, you can confidently assess whether the genetic markers align with those expected in human or animal DNA. Statistical significance plays a vital role here; it helps determine if the observed genetic variations are meaningful or just random fluctuations. If the data show high statistical significance, it suggests that the findings are reliable and not due to chance. Conversely, low significance indicates a need for caution before drawing conclusions. Overall, these results help you understand whether the samples contain typical human DNA, animal DNA, or something unusual, guiding further investigations into their true origins.
Common Challenges and Limitations in Genetic Testing of Hair
When testing hair samples, you often face limited amounts of usable DNA, which can make obtaining reliable results difficult. Contamination from environmental sources or handling also poses a significant challenge, risking false positives or skewed data. Recognizing these issues is essential for improving the accuracy of genetic analysis in such samples.
DNA Quantity ConstraintsGenetic testing of hair samples often faces significant hurdles due to the limited amount of DNA they contain. This small sample size makes it difficult to obtain enough genetic material for analysis, especially when dealing with degraded or old samples. Here are some common challenges:
Insufficient sample size limits the amount of DNA available for testing.DNA degradation from environmental exposure reduces extractable genetic material.Low DNA yield complicates amplification, risking incomplete or inaccurate results.Contamination risks become more problematic when working with tiny amounts of DNA.These constraints mean you need highly sensitive techniques and meticulous handling to ensure reliable results, especially when trying to identify or analyze suspect hair samples from mythical creatures like werewolves.
Contamination RisksContamination risks pose a significant obstacle in genetic testing of hair samples, especially when working with tiny amounts of DNA. Environmental contamination from dust, skin cells, or other biological material can easily compromise results. Even minor contact with contaminated surfaces or tools can introduce foreign DNA, leading to false positives or ambiguous findings. To mitigate these risks, strict lab safety protocols must be followed, including wearing gloves, using sterile equipment, and working within clean environments. Proper sample handling minimizes the chance of contamination and ensures test accuracy. Vigilance is essential, as even unintentional contamination could distort the genetic profile, making it difficult to draw conclusive results about the hair’s origin or genetic makeup.
The Role of Contamination and Human Error in Sample Analysis
Despite rigorous protocols, contamination and human error can considerably impact the accuracy of sample analysis in CRISPR screens. Proper contamination control is essential, but mistakes happen. Human error, like mislabeling samples or overlooking contamination, can skew results. To minimize these risks, you should:
Strictly follow contamination control procedures to prevent cross-sample mix-upsDouble-check labels and data entries to reduce human errorUse sterile equipment and work in clean environmentsImplement multiple review steps during analysis to catch mistakes earlyEven small lapses can lead to false positives or negatives, affecting interpretations. Recognizing the influence of contamination and human error helps guarantee more reliable, valid results in your CRISPR investigations.
Distinguishing Between Science and Sensationalism in Cryptid Claims
When evaluating claims about mysterious creatures like alleged werewolves, it’s crucial to differentiate solid scientific evidence from sensationalism. Media sensationalism often amplifies cryptid stories to attract viewers, overshadowing credible research. Myth busting plays a fundamental role in clarifying misconceptions and promoting scientific integrity. To see this clearly, consider the table below:
AspectScientific ApproachSensationalist ClaimsEvidenceEmpirical, replicable experimentsAnecdotal, unverified storiesMedia RepresentationFact-based reportingExaggeration and fearmongeringPeer ReviewCritical evaluation by expertsLack of scrutinySource CredibilityReputable scientific sourcesUnverified, sensational outletsOutcomeInformed understandingMisleading beliefsFrequently Asked QuestionsCan CRISPR Definitively Prove the Existence of Werewolves?You might wonder if CRISPR can definitively prove werewolves exist, but it can’t. DNA verification can identify species or mutations, yet it can’t confirm supernatural entities. Using CRISPR raises ethical implications, especially when testing uncertain samples. While it helps analyze genetic material, it doesn’t provide proof of mythical creatures. So, no, CRISPR alone can’t prove werewolves’ existence; it’s limited to scientific data, not supernatural phenomena.
How Reliable Are Hair Samples in Identifying Mythical Creatures?Imagine peering into a misty forest, where shadows hide secrets. Hair analysis offers clues, but it’s not foolproof for myth verification. You can’t rely solely on hair samples to identify mythical creatures; they often resemble ordinary animals. While advanced techniques like CRISPR help investigate DNA, the reliability remains limited. So, you’d need more evidence to confidently distinguish fact from fiction in such enigmatic cases.
What Are the Ethical Concerns Surrounding Genetic Testing of Alleged Cryptid Samples?When considering genetic testing of cryptid samples, you should think about ethical concerns like privacy worries and consent issues. You might unintentionally expose sensitive genetic information or misuse it. Plus, if the sample belongs to someone or something, obtaining proper consent is vital. Without clear guidelines, you risk infringing on privacy rights or causing harm, so it’s necessary to handle such testing responsibly and ethically.
Could Human Error Lead to False Positives in Werewolf DNA Analysis?You might think human oversight guarantees perfect results, but ironically, it can introduce contamination risks, leading to false positives in werewolf DNA analysis. Human error, from sample mishandling to misinterpretation, lurks behind every step. While advanced techniques aim for accuracy, your own mistakes could turn a regular hair sample into evidence of mythical creatures. So, beware—sometimes, it’s not the creature you find, but the mistakes you make.
Are There Legal Restrictions on Conducting CRISPR Research on Cryptid Remains?You should know that cryptid legislation and research restrictions vary widely depending on your location. Some areas have strict laws protecting unknown species or remains, which could limit your ability to conduct CRISPR research on cryptid remains. Before proceeding, you need to check local regulations and verify you’re compliant, as unauthorized research might lead to legal trouble. Always prioritize legal guidance to avoid violations of cryptid legislation and research restrictions.
ConclusionWhile CRISPR screens offer exciting insights into hair samples, remember that science isn’t foolproof—mistakes and contamination can muddy the waters. Don’t jump to conclusions based on sensational stories; often, it’s a case of chasing shadows. Keep a level head and trust rigorous testing over hype. In the end, it’s better to be safe than sorry, especially when unraveling mysteries that blur the line between fact and fiction.
August 19, 2025
Bioluminescence Studies and the Truth Behind Deep‑Sea Serpents
Bioluminescence studies reveal that many deep-sea serpent sightings likely result from glowing marine creatures, like fish and other organisms, that produce light through chemical reactions. These luminous displays can appear mysterious and giant, fueling legends of mythical monsters. As technology improves, scientists better understand these animals’ behaviors and how bioluminescence creates illusions of sea serpents. To uncover more about these fascinating marine mysteries, keep exploring the secrets hidden in the ocean depths.
Key TakeawaysBioluminescent mechanisms reveal how deep-sea creatures produce light for communication, camouflage, and predation, clarifying their mysterious behaviors.Deep-sea serpent legends likely originated from sightings of bioluminescent marine animals mistaken for mythical creatures.Advances in exploration technology enable scientists to observe and document bioluminescent species, demystifying legends of sea serpents.Many reported deep-sea serpent sightings may be misinterpretations of glowing marine organisms or bioluminescent phenomena.Ongoing research links bioluminescence to survival strategies, helping distinguish between myth and scientific understanding of deep-sea life.The Origins of Deep-Sea Serpent Legends
Many legends of deep-sea serpents likely originate from early sailors’ encounters with mysterious, glowing creatures in the ocean’s depths. These myth origins are shaped by sailors’ stories, which often involved sightings of strange, luminous beings that appeared in the dark waters. Over time, these accounts merged with local cultural influences, transforming into stories of monstrous serpents and sea monsters. Different cultures, from European to Asian traditions, have contributed unique interpretations, emphasizing serpent-like creatures as symbols of chaos or divine power. The glow of bioluminescent creatures, combined with limited visibility and the human tendency to anthropomorphize unfamiliar phenomena, fueled fears and legends. These stories persisted, solidifying their place in maritime folklore and influencing perceptions of the mysterious ocean depths.
How Bioluminescence Functions in Marine Life
You might wonder how marine creatures produce their glowing light and why they do it. Bioluminescence involves specialized mechanisms that generate light through chemical reactions, which serve various ecological purposes. Understanding these functions helps explain how deep-sea animals survive and communicate in the dark ocean depths.
Light Production MechanismsBioluminescence in marine life occurs through a precise chemical process that produces light without relying on external sources. This process mainly involves photoprotein mechanisms and luciferin interactions. When triggered, luciferin molecules react with enzymes, releasing energy as visible light. You’ll find that:
Photoproteins contain bound luciferin, activating upon stimulationLight emission results from specific enzymatic reactionsDifferent species use unique luciferin types for diverse colorsThe process is highly efficient, with minimal energy lossSome organisms control light by regulating photoprotein activityThis intricate system allows marine creatures to produce light on demand, essential for communication, camouflage, or attracting prey, all without sunlight’s help. The mechanisms are finely tuned, enabling the mesmerizing displays observed deep beneath the ocean’s surface.
Ecological Roles of BioluminescenceBioluminescence serves essential ecological functions that shape the behavior and survival strategies of deep-sea creatures. You see, it’s indispensable for bioluminescent communication, helping animals signal mates or coordinate with others in the dark. It also plays a critical role in predator-prey interactions; predators can use it to lure prey or warn rivals, while prey use it to hide or confuse predators.
FunctionExampleBioluminescent communicationMating displays among deep-sea fishPredator-prey interactionsLuring prey with glowing lures or startling predatorsCamouflageUsing bioluminescent patterns to blend into surroundingsDefense mechanismsSudden flashes to startle predatorsThese functions are key to survival, influencing how creatures hunt, communicate, and evade threats.
Recent Discoveries in Deep-Sea Bioluminescent Creatures
Recent discoveries have shed new light on the remarkable diversity of bioluminescent creatures inhabiting the deep sea. Scientists have uncovered species with astonishing adaptations, such as bioluminescent camouflage that helps them blend into the darkness. Some use predator-prey signaling to attract or deter others, showcasing complex communication. You might find creatures that emit flashing patterns to lure prey or confuse predators, enhancing their survival chances. Others display glowing appendages to navigate or locate mates in pitch-black environments. *Particularly*, new species with intricate light displays challenge previous assumptions about deep-sea life. Their ability to manipulate light reveals a sophisticated evolutionary toolkit. These insights deepen our understanding of how bioluminescence supports survival in one of Earth’s most extreme habitats.
Linking Sightings to Bioluminescent Phenomena
When researchers observe mysterious glowing patterns in the deep sea, they often link these sightings to specific bioluminescent phenomena. These lights serve as signals for bioluminescent communication, allowing creatures to identify each other or coordinate behavior in the darkness. Many sightings of strange, serpentine shapes are attributed to these luminous displays rather than actual organisms. Bioluminescence also plays a pivotal role in predator-prey interactions; predators use flashing lights to attract prey or confuse rivals, while prey species emit evasive signals. By analyzing the timing, color, and movement of these glows, scientists can better understand whether a sighting is a biological event or a mysterious creature. This link helps demystify deep-sea lights and supports theories behind deep-sea serpent legends.
Scientific Challenges in Studying Deep-Sea Organisms
Studying deep-sea organisms is tough because of the extreme depths where they live. You have limited chances to observe them without specialized equipment, which makes data collection difficult. These harsh conditions challenge scientists to develop innovative methods to understand these elusive creatures.
Extreme Depth ConditionsExploring the deep-sea environment presents formidable scientific challenges because of the extreme conditions that organisms must endure. You face crushing pressures exceeding 1,000 atmospheres, near-freezing temperatures, total darkness, and scarce nutrients. These factors complicate research efforts and limit observations. Deep-sea creatures rely heavily on bioluminescent signaling to communicate and attract prey or deter predators. Studying these adaptations is difficult because:
Equipment must withstand immense pressureLightless conditions hinder visual observationsMaintaining biological samples in situ is complexTracking predator-prey interactions requires advanced technologyUnderstanding bioluminescence’s role in survival is challengingThese harsh conditions shape unique adaptations, like bioluminescent displays, making the study of deep-sea organisms a demanding yet fascinating pursuit.
Limited Observation OpportunitiesThe extreme conditions of the deep sea considerably limit opportunities to observe its organisms directly. High pressure, near-freezing temperatures, and total darkness create significant observational limitations for researchers. These conditions challenge the deployment of traditional equipment, making it difficult to study marine adaptations in real time. Remote-operated vehicles and deep-sea submersibles help, but their range and duration are limited. Many deep-sea creatures exhibit unique adaptations, like bioluminescence, to survive and communicate, yet we often miss these behaviors due to limited visibility and short observation windows. As a result, our understanding of deep-sea organisms remains incomplete, and many mysteries about their biology and behavior persist. Overcoming these observational limitations requires technological innovation and innovative exploration strategies.
Future Prospects for Unveiling Oceanic Mysteries
Advances in underwater technology are opening new frontiers for uncovering the ocean’s hidden secrets. With technological innovations like autonomous underwater vehicles, high-resolution sonar, and deep-sea drones, you’ll explore previously unreachable depths. Interdisciplinary collaborations between marine biologists, engineers, and data scientists accelerate discoveries, enabling real-time data analysis and improved imaging. Future prospects include mapping uncharted habitats, identifying new species, and understanding bioluminescent behaviors linked to elusive phenomena like deep-sea serpents. As these tools become more sophisticated, you’ll gain clearer insights into the ocean’s mysteries. The potential to study bioluminescence, deep-sea ecosystems, and unknown creatures grows exponentially, promising breakthroughs that could redefine our understanding of the underwater world. The future is bright for ocean exploration.
Frequently Asked QuestionsAre There Any Confirmed Sightings of Actual Deep-Sea Serpents?You wonder if there are confirmed sightings of deep-sea serpents. While marine folklore and cryptid sightings have fueled speculation, no verified evidence proves their existence. Most reports remain anecdotal, often misidentifications or hoaxes. Despite intriguing stories, the scientific community hasn’t confirmed any actual sightings of these mysterious creatures. So, until credible proof emerges, deep-sea serpents stay within the domain of myth and legend rather than confirmed reality.
How Do Bioluminescent Patterns Differ Among Deep-Sea Species?You notice that bioluminescent patterns vary greatly among deep-sea species, showcasing incredible bioluminescent diversity. Some creatures emit steady glows, while others produce flashing or pulsating lights. Pattern recognition helps scientists identify species and understand their behaviors. These unique light displays serve purposes like communication, predation, or camouflage. By studying these patterns, you gain insight into the complex adaptations that allow life to thrive in the dark depths of the ocean.
Can Bioluminescence Be Used for Communication Among Marine Creatures?You might wonder if bioluminescence can be used for communication among marine creatures. The answer is yes—bioluminescent signaling plays a key role in marine communication, helping animals attract mates, ward off predators, or coordinate group behaviors. By emitting specific patterns or signals, these creatures can effectively convey messages in the dark depths of the ocean, making bioluminescence a essential tool for survival and interaction beneath the waves.
What Technological Advancements Are Aiding Deep-Sea Exploration?Imagine you’re exploring the ocean’s depths in a state-of-the-art submersible. Thanks to recent submersible innovations, you can now access previously unreachable areas. Remotely operated vehicles, or ROVs, allow you to capture high-resolution images and collect samples safely. These advancements make deep-sea exploration more efficient, revealing hidden ecosystems and mysterious creatures, ultimately expanding our understanding of the ocean’s deepest mysteries.
Could Bioluminescent Signals Be Mistaken for Mythical Sea Monsters?You might wonder if bioluminescent signals could be mistaken for mythical sea monsters. It’s possible because some creatures use bioluminescent mimicry and marine camouflage to blend into their surroundings or imitate larger animals. These adaptations can create illusions in low light, confusing observers. So, what seems like a sea monster might just be a cleverly camouflaged or mimicking deep-sea creature using bioluminescence to survive.
ConclusionAs you explore the mysteries of deep-sea serpents, remember that over 80% of the ocean remains unexplored, hiding countless bioluminescent creatures just waiting to be discovered. Bioluminescence not only explains many strange sightings but also reveals the ocean’s astonishing diversity. With advancing technology, you’ll soon uncover even more secrets from the depths, proving that the true story behind these legendary creatures is still unfolding, one luminous discovery at a time.
August 17, 2025
When Seismographs Detect Footsteps: Measuring Giant Humanoid Impact
When seismographs detect unusual ground vibrations resembling footsteps, scientists analyze for specific patterns and frequencies that distinguish these signals from natural earthquakes or human activity. Advanced technology helps filter noise and verify if these vibrations are caused by giant humanoids or myths. By studying these seismic signals closely, researchers aim to separate legend from science. If you’re curious how these discoveries could reshape our understanding, there’s much more to explore beneath the surface.
Key TakeawaysSeismographs detect ground vibrations caused by footsteps, requiring sensitive calibration to distinguish them from natural and environmental noise.Footstep impacts from giant humanoids produce specific seismic signatures, including low-frequency tremors and unique pattern sequences.Differentiating natural seismic events from cryptid footsteps involves analyzing vibration patterns, frequency, and correlating environmental data.Modern technology like biometric sensors and drones enhances the detection, verification, and localization of giant footprints via seismic signals.Accurate measurement of seismic footprints can potentially validate legends, offering insights into unknown creatures and expanding scientific understanding.The Science Behind Seismograph Sensitivity
Seismographs are incredibly sensitive instruments designed to detect ground movements, even those caused by tiny vibrations like footsteps. To achieve this, they require precise sensitivity calibration, ensuring they pick up relevant signals while ignoring irrelevant ones. This calibration adjusts the instrument’s response to different vibration levels, helping distinguish between actual seismic events and background signal noise. Signal noise, caused by environmental factors such as wind or nearby machinery, can obscure subtle ground movements. Proper calibration minimizes this interference, allowing the seismograph to detect faint signals like footsteps accurately. The fine-tuning process involves setting thresholds and filtering out high-frequency noise, so only meaningful vibrations are recorded. This meticulous calibration is essential for analyzing tiny signals and understanding their true origins.
Historical Cases and Anecdotal Evidence
Throughout history, people have reported strange vibrations and unexplained footprints that seem to align with seismic data. Modern accounts continue to surface, often correlating with seismograph readings. These stories and reports give intriguing clues about how seismic evidence can connect to real-world events.
Ancient Sightings and StoriesHave ancient civilizations documented mysterious footsteps that modern science now detects with seismographs? Throughout history, folklore legends and stories of mythical creatures often referenced massive, unseen beings. These tales may hold more truth than we realize. Consider:
Ancient cave paintings hinting at colossal footprints linked to legendary giants.Indigenous stories describing footsteps that shook the earth, suggesting massive entities.Medieval legends of monstrous beings whose presence caused tremors.Cultural myths portraying creatures so large they left lasting impressions on the land.Could these stories reflect real encounters with giant humanoids? Modern seismographs might be revealing echoes of these ancient sightings, connecting folklore legends with scientific evidence. What once was dismissed as myth now gains new significance through technological discovery.
Modern Footprint ReportsHistorical reports and anecdotal accounts of mysterious footprints have long intrigued researchers and enthusiasts alike. Many urban legends describe enormous footprints found in remote areas, fueling speculation about cryptid sightings like Bigfoot or other giant humanoids. These stories often lack concrete evidence but persist across generations, sparking curiosity and debates. Witnesses claim to have seen huge footprints in forests, fields, or snow, sometimes accompanied by strange sounds or unexplained phenomena. Modern explorers and enthusiasts document these reports, comparing them with recent seismic or sensor data. While skeptics dismiss them as hoaxes or misidentifications, believers see these footprints as clues to elusive giant creatures. These reports keep the mystery alive, encouraging ongoing investigations into the possibility of extraordinary beings lurking just beyond our perception.
Seismic Evidence CorrelationsWhen examining historical cases and anecdotal evidence of mysterious footprints, seismic data often reveals intriguing correlations that suggest more than just coincidence. These seismic evidence correlations link biological footprints and geological anomalies to unexplained seismic tremors. Consider these points:
Some seismic events coincide precisely with reports of large footprints, hinting at unseen giant beings.Geological anomalies, like unusual ground vibrations, often align with sightings of mysterious creatures.In certain cases, seismic signals match footprints found in remote areas, supporting the idea of enormous, unseen footsteps.These correlations challenge conventional explanations, raising questions about hidden biological footprints and the seismic impact of unknown giants lurking in history. Such connections fuel curiosity and deepen the mystery of what walks among us unseen.Differentiating Natural and Unexplained Signals
Differentiating between natural seismic signals and unexplained anomalies is crucial for accurate interpretation of seismograph data. Natural signals often result from earthquakes, weather, or human activity, while cryptid signals can mimic these patterns but lack consistent sources. To avoid false alarms, you need to analyze the signal’s characteristics—such as frequency, duration, and pattern. Cryptid signals may appear sporadically and lack the typical seismic signatures of natural events. By cross-referencing data with environmental factors and known activity, you can filter out false alarms and identify genuine anomalies. Recognizing these differences ensures that mysterious footsteps or cryptid signals aren’t dismissed or misclassified, helping you focus on truly unexplained seismic events that merit further investigation.
Technological Advances in Detecting Massive Footsteps
Recent advancements in seismic technology have considerably improved our ability to detect massive footsteps, especially those that might be linked to cryptid activity. Modern tools like biometric sensors can now analyze subtle vibrations with incredible precision, alerting us to unusual movements. Drone surveillance adds another layer, providing real-time visuals that help confirm seismic signals.
You should feel a surge of excitement when these innovations lead to breakthroughs. Consider:
The thrill of discovering new evidence through cutting-edge sensorsThe adrenaline rush when drones capture elusive footprintsThe hope of finally uncovering hidden giants among usThe satisfaction of technological progress opening new frontiersTogether, biometric sensors and drone surveillance are revolutionizing how we detect and understand giant footsteps.
Challenges in Verifying Giant Humanoid Footsteps
Verifying giant humanoid footsteps remains a significant challenge because seismic signals can easily be mistaken for natural or human-made disturbances. Authenticity challenges arise as you try to distinguish genuine giant footsteps from everyday noise, like earthquakes, vehicles, or wildlife. Sensory limitations further complicate validation since seismographs may not capture all relevant details, making it hard to confirm the source definitively. You must analyze subtle differences in seismic patterns, but these can be ambiguous, leading to doubts about authenticity. Without clear, consistent signatures, you risk misinterpreting signals or dismissing real evidence. Overcoming these challenges requires advanced filtering techniques and corroborative data, but until then, verifying such footprints remains a complex, uncertain process.
Potential Implications of Confirmed Discoveries
Confirming the existence of giant humanoid footprints would mark a groundbreaking moment with far-reaching consequences. It could challenge your understanding of history and ignite debates across cultures. Consider these potential impacts:
Cultural implications: Traditions and legends might gain credibility, reshaping identities and beliefs worldwide.Scientific skepticism: Experts may question established theories, prompting rigorous research and new methodologies.Public curiosity: Widespread fascination could foster increased interest in exploration and discovery.Ethical debates: Questions about the protection of these mysterious beings might emerge, influencing policy and conservation efforts.While skepticism remains, the discovery would force you to reconsider what’s scientifically possible, blending myth with reality and transforming your worldview.
Future Prospects for Seismology and Mythology
As seismology advances, it opens new pathways for exploring the boundaries between myth and reality. Future research could validate cryptid folklore by detecting unique seismic signals, revealing hidden truths behind legendary creatures. It also fuels extraterrestrial hypotheses, where unexplained vibrations might hint at alien activity. Your efforts could lead to breakthroughs that challenge conventional understanding of Earth’s mysteries. Consider this table:
Potential DiscoveriesImpact on MythologyScientific SignificanceSeismic signs of cryptidsConfirming folklore storiesExpanding biological knowledgeUnexplained seismic patternsSupporting extraterrestrial hypothesesAdvancing seismology techniquesNew detection technologiesBridging myth and scienceImproving earthquake predictionThese prospects excite you to explore deeper, blurring lines between legend and science.
Frequently Asked QuestionsCould Giant Humanoids Have Existed Undetected by Modern Science?You wonder if giant humanoids could have existed undetected by modern science. It’s possible ancient civilizations told stories about mythical creatures, which might hint at real encounters. Still, no concrete evidence supports their existence today. Seismographs and other technology help us detect massive impacts, but if giants lived quietly, they’d likely leave little trace. So, while intriguing, there’s no solid proof they ever roamed unnoticed.
What Are the Legal and Ethical Issues in Investigating These Signals?Imagine you find strange seismic signals suggesting giant humanoids, but legal and ethical issues arise. You must consider privacy concerns, especially if local communities are involved or affected. Research ethics demand transparency and consent, ensuring your investigation doesn’t harm or exploit others. For instance, conducting covert studies could breach trust and legal standards, so you need clear guidelines and respect for all parties to ethically explore such extraordinary claims.
How Do Cultural Myths Influence Scientific Interpretations of Seismic Data?You might not realize it, but cultural myths and biases shape how you interpret seismic data. Mythical narratives can lead you to see giant humanoids or supernatural beings in the signals, even when scientific evidence points elsewhere. These cultural influences can skew your understanding, making you more prone to sensational ideas rather than objective analysis. Recognizing these biases helps you stay grounded in scientific rigor, separating myth from measurable reality.
Are There Potential Risks Associated With Confirming the Existence of Such Beings?Discovering giant humanoids could be the biggest breakthrough in science, but it also brings serious risks. You might face privacy concerns if governments or organizations try to hide or control the data. Confirming such beings could challenge scientific credibility, leading to skepticism or panic. You need to weigh these risks carefully, ensuring transparency and responsible research, so society can handle the truth without chaos or loss of trust.
How Might This Discovery Impact Our Understanding of Human Evolution?You’d see a major shift in understanding human evolution, as this discovery would challenge the fossil record and reshape the evolutionary timeline. It suggests that giant humanoids might have coexisted with early humans, prompting you to reevaluate how humans evolved and interacted with other species. This breakthrough could fill gaps in our knowledge, revealing new evolutionary pathways and expanding your perspective on our ancient ancestors.
ConclusionImagine detecting footsteps from beings over 100 meters tall through seismographs. With sensitivity levels improving by 30% each year, scientists are closer than ever to verifying these giant footprints. If confirmed, it could redefine our understanding of myth and reality. So, stay curious—seismology might just hold the key to uncovering legends buried deep beneath our feet, revealing that, sometimes, the extraordinary is within reach if you know where to look.
August 16, 2025
Using LIDAR to Uncover Hidden Lairs Beneath Ancient Forests
Using LIDAR to uncover hidden lairs beneath ancient forests involves emitting rapid laser pulses from aerial platforms that penetrate dense vegetation and canopy interference. This technology measures return times to create detailed 3D landscape models, revealing subtle terrain features and underground structures often concealed by vegetation. By filtering out irrelevant signals and combining data with other methods, you can identify walls, tunnels, and pathways that remain invisible to surface surveys. To discover more about how this fascinating process works, keep exploring further.
Key TakeawaysLIDAR penetrates dense forest canopies to reveal concealed underground chambers, tunnels, and structural remnants.Advanced data processing filters noise and distinguishes natural terrain from man-made features.Multiple scan angles and lower vegetation analysis improve detection of hidden lairs beneath foliage.Integrating LIDAR with other remote sensing methods enhances accuracy in locating subterranean structures.Ethical considerations and terrain challenges must be managed for responsible and effective discovery of hidden habitats.The Principles Behind LIDAR Technology
LIDAR technology works by sending out rapid pulses of laser light toward the ground from an aerial platform, such as a drone or aircraft. This principles overview explains how it works using laser fundamentals: each pulse reflects off surfaces below and returns to the sensor. By measuring the time it takes for the laser to return, LIDAR calculates precise distances, creating detailed 3D models of the landscape. The laser’s wavelength and pulse rate are vital for accuracy. You’ll find that understanding these laser fundamentals helps clarify how LIDAR captures complex terrain features, even beneath dense forest canopies. This combination of rapid pulse emission and precise timing allows you to generate high-resolution maps, revealing hidden structures that are otherwise invisible to the naked eye.
Historical Challenges in Forest Archaeology
Deciphering ancient structures hidden beneath dense forests presents numerous obstacles. The thick forest canopy blocks sunlight, making ground surveys difficult. Wildlife disturbance is another issue, as many species react strongly to human presence, hindering excavation efforts. Additionally, the dense vegetation conceals archaeological remains, complicating identification.
ChallengeImpactForest canopyLimits visibility and aerial imaging clarityWildlife disturbanceDisrupts archaeological activitiesVegetation overgrowthHides structures from surface detectionThese challenges have historically slowed discoveries, forcing archaeologists to rely on invasive methods. Without advanced tools like LIDAR, uncovering ancient sites beneath such obstacles remains a significant hurdle.
How LIDAR Enhances Ground Surface Detection
By emitting laser pulses from an aircraft and measuring their return times, LIDAR can penetrate dense vegetation and forest canopy that normally obscures the ground. This technology diminishes the impact of canopy interference, allowing you to see beneath thick foliage. LIDAR’s ability to account for soil absorption ensures more accurate detection of ground features. It filters out signals reflected by leaves and branches, focusing on the ground surface. This enhances the clarity of terrain models, revealing subtle topographical details. With high-resolution data, you can identify ancient structures, terraces, and possible lairs hidden beneath the forest.
Reduces canopy interference for clear ground imagingAccounts for soil absorption to improve accuracyDifferentiates between vegetation and ground signalsReveals subtle topographical features often hidden from viewCase Studies of Hidden Structures Discovered With LIDAR
Throughout recent explorations, researchers have uncovered remarkable hidden structures beneath dense forests by analyzing LIDAR data. These discoveries reveal complex subterranean ecosystems, including underground chambers and networks previously obscured by vegetation. In one case, LIDAR revealed a series of ancient petroglyphs carved into hidden rock surfaces, offering insight into early human activity. Another project uncovered subterranean tunnels linked to ancient settlements, suggesting sophisticated engineering. These case studies demonstrate LIDAR’s power to expose features invisible to the naked eye, transforming our understanding of historical landscapes. By mapping beneath thick canopy cover, you gain access to a wealth of archaeological and ecological data, revealing secrets of past civilizations and natural habitats buried beneath centuries of forest growth.
Interpreting LIDAR Data: From Raw Points to Discoveries
Transforming raw LIDAR data into meaningful discoveries involves a series of precise steps that turn millions of points into detailed images of hidden structures. You start by filtering out noise and focusing on points beneath the tree canopy, revealing ground features. Data visualization tools help you interpret elevation differences and surface details, making subtle structures stand out. By analyzing the point cloud, you can identify features like walls, ditches, or chambers that were previously hidden. Effective interpretation depends on understanding the relationship between vegetation and terrain, especially when analyzing the dense tree canopy.
Filtering data to isolate ground pointsUsing color coding for elevation differencesEnhancing features with 3D visualizationRecognizing patterns beneath vegetationThe Role of LIDAR in Revealing Ancient Pathways and SettlementsTransforming raw LIDAR data reveals hidden structures beneath dense vegetation through precise filtering and visualization.

LIDAR technology helps you uncover hidden ancient pathways that are otherwise invisible beneath dense forests. It also reveals lost settlements, giving you a clearer picture of past human activity. By improving archaeological precision, LIDAR enables more accurate reconstructions of ancient landscapes.
Revealing Hidden PathwaysBy penetrating dense forest canopies, LIDAR technology uncovers hidden pathways and ancient routes that are invisible to the naked eye. It reveals underground tunnels and subtle ground features indicating long-forgotten trails. These pathways often connect settlements or serve as trade routes, offering insight into past civilizations. LIDAR’s ability to detect slight depressions and aligned features helps reconstruct the landscape’s original layout.
Uncovers underground tunnels that remain hidden under thick vegetationReveals faint linear features indicating ancient pathwaysDifferentiates between natural formations and man-made routesMaps complex networks that modern surveys might missThis technology transforms your understanding of how ancient peoples navigated their environment, illuminating pathways once concealed beneath the forest canopy.
Uncovering Lost SettlementsWhen dense forests obscure ancient settlements, LIDAR technology becomes an indispensable tool for uncovering what lies beneath the canopy. By revealing hidden structures and settlement layouts, LIDAR helps you piece together past societies’ ways of life. As you interpret these findings, engaging the public becomes essential—sharing discoveries fosters appreciation and support for preservation. However, ethical considerations must guide your work; respecting indigenous lands and cultural heritage remains paramount. You should verify that data collection and sharing adhere to local regulations and community wishes. Using LIDAR thoughtfully not only uncovers lost settlements but also promotes responsible archaeology, balancing scientific discovery with respect for the people and places involved. This approach ensures your work benefits both history and contemporary communities.
Enhancing Archaeological PrecisionEnhanced precision in archaeology relies on LIDAR’s ability to detect subtle surface features that traditional methods might overlook. By penetrating dense tree canopies, LIDAR reveals hidden pathways and settlements buried beneath complex forest layers. It also detects variations in soil composition, helping identify disturbed or altered earth indicative of past human activity. This technology fine-tunes site mapping, allowing you to pinpoint exact locations of ancient structures with remarkable accuracy.
Differentiates natural terrain from archaeological featuresIdentifies subtle topographical changes invisible to the naked eyeReveals hidden pathways that connect settlementsEnhances understanding of ancient landscape use and organizationOvercoming Vegetation and Terrain Obstacles
Vegetation density can obscure ground features, making it tricky to identify hidden structures. Terrain elevation changes add complexity to data collection and interpretation. To overcome these obstacles, advanced data processing techniques help filter out noise and enhance the visibility of underground features.
Vegetation Density ChallengesDense vegetation and complex terrain often obstruct LIDAR signals, making it challenging to detect hidden structures beneath thick forests. Canopy interference caused by dense foliage blocks the laser pulses, reducing data accuracy. Additionally, the root system can create false positives by mimicking man-made features. To overcome this, you must refine data processing techniques and filter out irrelevant signals. Key strategies include:
Using multiple scan angles to reduce canopy interferenceApplying advanced algorithms to distinguish natural from artificial featuresCombining LIDAR data with other remote sensing methodsFocusing on lower vegetation layers to minimize signal obstructionTerrain Elevation VariationsVariations in terrain elevation can considerably hinder LIDAR’s ability to accurately detect hidden structures beneath forests. Sudden changes in elevation, like hills or depressions, can obscure features and create gaps in data. Soil composition and moisture levels influence ground reflectivity, affecting LIDAR signals’ penetration. You might notice that areas with high moisture or dense soil absorb or scatter laser pulses, reducing clarity. To visualize this, consider the following:
Terrain FeatureEffect on LIDAR DataTip for ImprovementSteep slopesSignal distortionUse multiple scan anglesFlat plainsBetter detectionAdjust pulse intensitySoil moistureReduced penetrationIncorporate soil data analysisUnderstanding these factors helps you interpret LIDAR data more effectively, overcoming terrain obstacles.
Data Processing TechniquesEffective data processing techniques are essential for extracting meaningful information from LIDAR scans, especially when vegetation and terrain features obscure ground details. Tree canopies often hide the terrain below, making it difficult to identify hidden structures. To overcome this, you can use advanced algorithms to filter out canopy points, revealing the ground surface. Drone surveying complements this by capturing high-resolution data from multiple angles, improving accuracy. By carefully processing the data, you can distinguish between vegetation and terrain features, uncovering hidden lairs beneath dense forests.
Applying canopy point removal algorithmsUsing digital elevation models (DEMs)Combining drone survey data for detail enhancementEmploying filter-based techniques to isolate ground pointsIntegrating LIDAR With Other Archaeological Methods
While LIDAR provides unparalleled insights into hidden features beneath forest canopies, combining it with traditional archaeological methods enhances overall discovery and interpretation. Ground surveys and excavations complement LIDAR data by verifying and contextualizing detected structures. Examining soil composition helps identify areas with unusual nutrient levels or disturbances, confirming potential archaeological sites. Additionally, analyzing artifacts and features found during excavation can reveal cultural significance and chronological information. Integrating these methods allows you to cross-validate LIDAR findings, reducing false positives caused by vegetation or natural formations. This holistic approach creates a clearer picture of the landscape, enabling you to uncover buried structures more confidently and interpret their purpose within the broader historical context.
Future Prospects and Innovations in Forest Exploration
Future advancements will likely improve mapping precision, allowing you to reveal even the most hidden structures beneath dense forests. The integration of AI technologies promises to make data analysis faster and more accurate, giving you deeper insights. These innovations will transform how you explore and understand ancient landscapes.
Enhanced Mapping CapabilitiesAdvancements in LIDAR technology are set to revolutionize how you map and explore ancient forests. Improved accuracy in LIDAR calibration guarantees detailed, reliable data. This enables precise forest canopy analysis, revealing structures hidden beneath thick foliage. Enhanced mapping capabilities allow you to detect subtle terrain features and concealed lairs more effectively.
Higher resolution data for detailed terrain modelsFaster data processing and real-time analysisIncreased flight efficiency for large-area surveysBetter integration with other remote sensing toolsThese innovations enable you to uncover hidden features that traditional methods might miss. As LIDAR calibration improves, so does your ability to produce comprehensive, accurate maps, unblocking new insights into ancient forest ecosystems.
Integration of AI TechnologiesIntegrating AI technologies with LIDAR systems promises to transform forest exploration by enabling real-time analysis and autonomous data interpretation. You can leverage AI to enhance drone mapping, allowing quick, precise surveys of dense forests. This integration also helps assess climate impact by analyzing changes over time, guiding conservation efforts. AI algorithms can identify subtle terrain variations indicating hidden lairs or ancient structures, saving time and resources. Additionally, AI-driven models improve the accuracy of LIDAR data, making detection more reliable. As AI advances, expect smarter drones that independently map complex terrains and analyze environmental factors, unlocking new insights beneath forests. This synergy between AI and LIDAR will revolutionize how we explore, monitor, and protect these vital ecosystems.
TechnologyApplicationBenefitDrone mappingRapid forest surveysFast, detailed data collectionAI analysisReal-time data interpretationAccurate, immediate insightsClimate impactMonitoring environmental changesBetter conservation strategiesAutonomous dronesTraversing complex terrainsReduced human effortHidden lair detectionIdentifying unseen structuresUnlocking hidden secretsPreserving and Protecting Uncovered Heritage Sites
As uncovering hidden heritage sites becomes easier through technologies like LIDAR, it’s vital to focus on preserving and protecting these invaluable discoveries. Your role in cultural preservation and archaeological conservation is essential to ensure these sites remain intact for future generations. You must implement strict measures to prevent vandalism and illegal excavation. Collaborate with local communities to foster respect and awareness. Proper documentation and digital archiving can help safeguard the sites even if physical damage occurs.
Develop conservation plans that prioritize minimal environmental impactEnforce legal protections to deter unauthorized accessEducate the public about the significance of these sitesSupport sustainable tourism to balance access with preservation effortsFrequently Asked QuestionsHow Accurate Is LIDAR in Detecting Sub-Surface Archaeological Features?Protect and preserve hidden heritage sites through collaboration, legal safeguards, and responsible conservation efforts for future generations.
You might wonder how accurate LIDAR is for detecting subsurface archaeological features. In remote sensing, LIDAR provides highly detailed surface data, but its ability to reveal underground structures depends on data interpretation and environmental factors like vegetation and soil conditions. While it can uncover hidden features with impressive precision, it’s often combined with other methods for confirmation. Overall, LIDAR’s accuracy is excellent but not infallible on its own.
Can LIDAR Differentiate Between Natural and Man-Made Structures?You can rely on LIDAR for natural feature differentiation and artifact identification, but it’s not perfect. It spots subtle surface variations caused by buried structures, helping you distinguish between natural formations and man-made features. While LIDAR enhances your ability to differentiate, you might need supplementary methods like ground verification to confirm findings, especially in complex environments where natural features mimic archaeological artifacts.
What Limitations Does Dense Vegetation Impose on LIDAR Surveys?Dense vegetation can notably limit your lidar surveys because canopy interference and vegetation density obscure the ground. Thick foliage absorbs and scatters laser pulses, making it harder to get clear terrain data. When vegetation is especially dense, you might miss subtle features or structures beneath the canopy. To improve results, you need to adjust scanning angles, use higher-powered lasers, or combine lidar with other remote sensing methods.
How Cost-Effective Is LIDAR Compared to Traditional Archaeological Methods?You’ll find that lidar is often more cost-effective than traditional archaeological methods because of recent technological advancements. It offers quicker, more detailed surveys, reducing excavation costs and time. While initial investment can be high, the long-term economic feasibility improves as lidar uncovers hidden sites faster and with less disruption. Overall, lidar’s efficiency and accuracy make it a valuable tool, especially when compared to labor-intensive, traditional techniques.
Are There Ethical Concerns Related to Discovering and Excavating Hidden Sites?You might find it fascinating that over 60% of archaeologists believe ethical concerns are key in discovering hidden sites. When you use LIDAR, you should consider privacy concerns, especially with local communities, and prioritize cultural heritage preservation. Respecting these issues guarantees that your discoveries honor history without causing harm. Balancing technological advances with ethical responsibilities protects the sites and the cultures connected to them, making your work both groundbreaking and respectful.
ConclusionBy now, you see how LIDAR transforms forest archaeology, revealing hidden structures thought unreachable. Some argue it’s just a fancy tool, but evidence shows it uncovers real, ancient sites beneath dense foliage. As technology advances, you’ll discover even more secrets lurking beneath the trees. Embrace this innovation, and you might just uncover the mysteries of civilizations long lost to time, proving that LIDAR isn’t just a theory—it’s a game-changer in uncovering our past.
August 14, 2025
Acoustic Profiling of Mysterious Howls in the Pacific Northwest
Using acoustic profiling tools, you can analyze the unique sounds of mysterious howls in the Pacific Northwest. By examining their frequency patterns and comparing them with known wildlife calls, you can identify or differentiate unexplained sounds. Advanced technologies like spectral analysis and machine learning help uncover distinctive signatures, revealing whether these noises come from animals, environmental phenomena, or something more mysterious. Keep exploring to discover how these techniques uncover the secrets hidden in the soundscape.
Key TakeawaysSpectral analysis visualizes frequency signatures to differentiate mysterious howls from known wildlife sounds in the Pacific Northwest.Machine learning algorithms classify and identify patterns in recordings, aiding in distinguishing supernatural or unidentified sources.Strategic sensor placement captures elusive or haunting sounds amidst dense forests and rugged terrains.Cross-referencing with sound libraries helps determine if howls originate from local fauna or unknown phenomena.Acoustic modeling enhances understanding of how mysterious sounds propagate through varied landscapes and atmospheric conditions.The Unique Soundscape of the Pacific Northwest
The Pacific Northwest boasts a distinctive soundscape shaped by its diverse natural environment. You might imagine echoes of mythical creatures lurking in the forests or hear distant calls that have persisted through time. Historical recordings reveal a rich tapestry of sounds, from native bird calls to the mysterious howls that still puzzle researchers today. These recordings capture the region’s haunting melodies, blending natural and possibly supernatural elements. The landscape’s dense woods, rugged coastlines, and mountain ranges create an acoustical environment that amplifies these sounds, making them feel larger than life. Whether real or legend, the sounds of the Pacific Northwest evoke a sense of mystery and intrigue, inviting you to explore further and listen closely to its ancient, enthralling soundscape.
Techniques in Acoustic Data Collection
To gather accurate sound data, you need to carefully select your equipment and set up sensors in strategic locations. Once collected, analyzing the audio requires effective methods to distinguish notable patterns from background noise. Understanding these techniques helps you capture clearer recordings and interpret mysterious howls more effectively.
Equipment and Sensor SetupSetting up effective acoustic monitoring in the Pacific Northwest requires selecting the right equipment and sensors tailored to capture the elusive howls. You’ll want high-quality microphones with wide frequency ranges and low noise levels. Proper sensor calibration guarantees accurate recordings and reliable data. Use durable, weather-resistant enclosures to safeguard equipment from the region’s elements. Adequate data storage options, like large-capacity SD cards or external drives, are essential for handling continuous recordings. To optimize setup, consider the following:
Equipment TypePurposeKey FeaturesMicrophonesCapture high-fidelity soundsWide frequency response, low noiseData LoggersRecord and store dataLarge storage capacityPower SuppliesSustain long-term monitoringSolar panels, batteriesEnclosuresProtect equipmentWeather-resistant, durableCalibration ToolsGuarantee sensor accuracyCalibration software or devicesData Analysis MethodsAnalyzing acoustic data from the Pacific Northwest’s mysterious howls involves applying a variety of techniques designed to extract meaningful patterns and identify the sources. You’ll start by using spectral analysis to visualize sound frequencies, helping you distinguish wildlife communication signals from ambient noise. Time-domain analysis allows you to examine how sounds evolve over time, revealing behavioral patterns. Machine learning algorithms can classify different call types, assisting in identifying species or sources. Cross-referencing recordings with known wildlife communication helps confirm the origins of the howls. This process supports acoustic ecology by understanding soundscapes and ecosystem health. By combining these methods, you gain insights into the acoustic environment, revealing the roles of various animals and environmental factors behind the mysterious sounds.
Analyzing Frequency and Pattern Signatures
To identify mysterious howls, you focus on analyzing their frequency spectrum and pattern signatures. These techniques help distinguish different sources and behaviors behind the sounds. By applying pattern recognition, you can compare recordings and uncover unique acoustic signatures.
Frequency Spectrum AnalysisBy examining the frequency spectrum of the mysterious howls, researchers can identify distinct signature patterns that differentiate these sounds from other natural or human-made noises. This process reveals the spectral fingerprints unique to each call, allowing for precise comparison across recordings. You’ll notice how these ethereal melodies often contain specific frequency ranges that stand out, hinting at their possible origin or purpose. Analyzing the spectral content helps isolate key features like pitch, harmonics, and tonal quality, providing insight into the sound’s structure. This detailed approach enables you to distinguish between different sources and identify consistent patterns that may be linked to a particular creature or phenomenon. Ultimately, frequency spectrum analysis serves as a critical foundation for understanding the mysterious howls’ acoustic signatures.
Pattern Recognition TechniquesPattern recognition techniques play an essential role in identifying and classifying the mysterious howls by examining their frequency and signature patterns. You can utilize vocal pattern recognition to compare sound recordings, highlighting unique features in each howl. This approach helps differentiate sounds by their sound signature, revealing subtle variations that distinguish one creature or source from another. By analyzing these patterns, you can detect consistent traits such as pitch, tone, and rhythm. Sound signature differentiation allows you to filter out background noise and focus on distinctive acoustic signatures. Implementing algorithms for pattern recognition streamlines the process, enabling rapid and accurate identification. Ultimately, these techniques help you uncover clues about the origin of the howls and deepen your understanding of this mysterious phenomenon.
Differentiating Known From Unknown Sounds
Distinguishing known sounds from unknown ones requires careful analysis of acoustic features and contextual clues. Sound classification helps you identify familiar patterns, like calls from local wildlife or human activity. To isolate these, noise filtering becomes essential—removing background noise that could mask or distort the sounds. By focusing on specific frequency ranges and temporal patterns, you can differentiate between common, predictable noises and unfamiliar, potentially mysterious ones. Recognizing the characteristics of known sounds allows you to flag anomalies for further investigation. This process relies on comparing recordings to established sound libraries and understanding environmental context. Accurate differentiation is vital in narrowing down the source of mysterious howls and avoiding misinterpretation caused by overlapping noises.
Case Studies of Mysterious Howls
Several documented cases of mysterious howls in the Pacific Northwest have puzzled researchers and local residents alike. One notable case involved a series of eerie calls heard near ancient forests, sparking speculation about mythical creatures from local folklore legends. Witnesses described the sounds as haunting and unearthly, fueling legends of forest spirits or cryptid beasts, like the Sasquatch or other mythical entities. Experts struggled to identify the source, as the recordings showed unusual frequency patterns that didn’t match known animals. These cases often become part of local stories, blending fact and myth. While some dismiss them as natural phenomena, others believe they hint at mysterious beings rooted deep in regional folklore legends. These cases continue to inspire curiosity and debate among researchers and enthusiasts.
Technological Innovations in Sound Analysis
Advancements in sound analysis technology have revolutionized how you investigate mysterious noises like the haunting howls of the Pacific Northwest. You now utilize bioacoustic modeling to identify species-specific calls and classify sounds more accurately. Machine learning algorithms automatically analyze vast audio data, detecting patterns humans might miss. These innovations enable real-time monitoring and precise sound characterization. You can visualize the relationship between methods, applications, and outcomes in this table:
TechniqueApplicationBenefitBioacoustic modelingSpecies identificationAccurate call classificationMachine learning algorithmsAutomated sound pattern detectionIncreased analysis speedDeep neural networksComplex sound analysisEnhanced feature extractionReal-time processingField monitoringImmediate data insightsData visualization toolsPattern recognitionBetter understanding of soundscapeImplications for Wildlife and Ecosystem Research
The integration of advanced sound analysis technologies offers transformative potential for wildlife and ecosystem research. By analyzing mysterious howls, you can gain insights into animal behaviors and communication patterns, enriching your understanding of behavioral ecology. Precise sound propagation models help determine how sounds travel through various terrains and atmospheric conditions, revealing how animals might coordinate across distances. This approach enables you to monitor populations non-invasively, track migration routes, and identify species based solely on their calls. These insights can inform conservation strategies, habitat management, and ecosystem health assessments. As you refine acoustic profiling, you’ll better understand the complex interactions within ecosystems, helping you predict responses to environmental changes and human impacts. Ultimately, this research deepens your grasp of the intricate links between species and their habitats.
Frequently Asked QuestionsCould These Mysterious Howls Be Linked to Human Activities or Artifacts?You might wonder if these mysterious howls are connected to human activities or artifacts. It’s possible, as urban noise and mechanical sources like vehicles, construction, or industrial equipment can create sounds that resemble howls. Sometimes, these noises bounce off terrain or structures, making them seem eerie or unexplainable. So, investigating local human activities and mechanical sources could help identify whether they’re behind these strange sounds.
Are There Any Historical Reports of Similar Sounds Predating Modern Recordings?They say history repeats itself, and your question about ancient echoes is no exception. You might find that historical reports of similar sounds exist, often woven into ancient legends of mysterious creatures or spirits. These sounds, documented long before modern recordings, suggest that such phenomena have long captivated human imagination. Delving into old tales could reveal that these mysterious howls have been part of the region’s cultural fabric for generations.
How Might Climate Change Impact the Frequency of These Elusive Sounds?Climate change could increase the frequency of these mysterious sounds by amplifying drought effects, which stress local ecosystems. As water sources dwindle, animals may alter migration patterns or become more vocal in distress, leading to more frequent or intense howls. You might notice these sounds happening more often as wildlife responds to habitat changes, making it essential to monitor environmental shifts to understand their impact on animal behavior and communication.
Can Acoustic Profiling Conclusively Identify New or Hybrid Species?You might wonder if acoustic profiling can conclusively identify new or hybrid species. While it provides valuable data, it often requires supporting evidence like genetic analysis to confirm findings. By examining behavioral patterns alongside acoustic signatures, you increase accuracy. Ultimately, combining these methods helps you distinguish between known species, hybrids, and potentially new species, giving you a clearer understanding of the biodiversity you’re studying.
What Are the Potential Cultural or Mythological Interpretations of These Sounds?You might see these mysterious sounds as echoes of Indigenous legends, where mythical creatures like the Thunderbird or Wendigo are believed to produce such noises. These interpretations shape local culture, fueling stories that connect nature with spirituality. The sounds could symbolize spiritual messages or warnings, reinforcing cultural beliefs. You’ll find that many communities view these howls as part of their mythological heritage, blending natural phenomena with folklore and tradition.
ConclusionBy diving into these mysterious howls, you’re exploring a soundscape as complex as a tangled forest. As technology advances, you get closer to uncovering whether these calls are from elusive wildlife or something even stranger. Each discovery is like opening a new leaf in a vast, hidden book of nature’s secrets. Your efforts help protect ecosystems and deepen understanding, turning the unknown into the known—like shining a flashlight through the darkness of the Pacific Northwest.
August 13, 2025
DNA Barcoding of Mermaid “Scales”: What the Lab Results Show
DNA barcoding of mermaid scales shows surprising links to known marine species like fish and invertebrates, challenging myths about their origins. The lab results reveal that these scales often match common marine animals, suggesting they come from real biological sources rather than myth. However, some results are ambiguous or suggest unknown or hybrid species. To understand the full story behind these mysterious objects, there’s much more to explore in the genetic findings.
Key TakeawaysLab results show DNA sequences matching various marine species, indicating diverse origins for the mermaid scales.Many samples align with known fishes and invertebrates like herring, cod, octopus, and shrimp.Some genetic markers are ambiguous or do not match known species, suggesting possible new or hybrid mermaid variants.Preservation and contamination issues can influence results, highlighting the need for improved sampling techniques.Overall, DNA barcoding reveals complex biodiversity and challenges mythological assumptions about mermaid origins.The Origin of the Mysterious Scales
Many have wondered about the true origin of the mysterious mermaid scales, as their unique appearance sets them apart from typical fish or marine life. In marine folklore, these scales are often linked to mythological origins, inspiring stories of enchanted beings and underwater legends. Some believe they’re remnants of legendary mermaids, while others suggest they could be extraordinary natural phenomena mistaken for myth. Despite their enthralling tales, scientific evidence remains elusive. These scales’ distinctive shimmer and structure fuel speculation about their origins, blending myth and mystery. By exploring their mythological roots, you gain insight into how human imagination shapes our understanding of the ocean’s secrets, fueling curiosity and inspiring ongoing research into their true nature.
Methods Used in DNA Extraction and Sequencing
To obtain reliable DNA data, you need effective sample preservation techniques to prevent degradation. Next, selecting the right DNA extraction protocols guarantees you isolate high-quality genetic material. Finally, choosing suitable sequencing methodologies allows you to accurately decode the genetic information from the scales.
Sample Preservation TechniquesPreserving mermaid scale samples properly is essential for successful DNA extraction and accurate sequencing. The choice of preservation methods directly impacts sample integrity, guaranteeing the DNA remains intact and uncontaminated. Typically, samples are stored in ethanol or specialized preservatives like DMSO to prevent degradation. Freezing samples at low temperatures also helps maintain DNA quality over time. Avoiding exposure to heat, light, and moisture is critical, as these factors can break down genetic material. Labeling samples clearly and using sterile containers further safeguard sample integrity. Proper preservation techniques minimize DNA fragmentation and contamination, providing reliable material for subsequent analysis. By adhering to effective methods, you ensure high-quality DNA extraction, paving the way for accurate DNA barcoding results.
DNA Extraction ProtocolsExtracting DNA from mermaid scale samples involves carefully choosing the appropriate method to maximize yield and purity. Since mermaids are mythological origins, their scales often have scaleless skin or minimal tissue, making extraction challenging. You need a protocol that effectively breaks down the unique tissue structure without contamination. Using commercial DNA extraction kits designed for low-yield samples can help ensure high-quality DNA. You’ll typically start with tissue lysis, followed by purification steps that remove proteins and other contaminants. Be mindful of potential inhibitors from the scale’s composition, which can affect downstream processes. Precision during extraction is key to obtaining viable DNA for barcoding, especially given the mythological nature of the samples. Proper protocols ensure reliable results and accurate species identification.
Sequencing MethodologiesSequencing methodologies are vital for accurately analyzing DNA extracted from mermaid scales, especially given the limited and challenging samples involved. You typically use high-throughput techniques like Sanger sequencing or Next-Generation Sequencing (NGS) to obtain detailed genetic information. These methods enable you to assess genetic diversity within and between mermaid populations, providing insights into their evolutionary history. By comparing sequences, you can track molecular evolution and identify mutations or adaptations. Choosing the right sequencing approach guarantees reliable data, indispensable for understanding species variation and evolutionary patterns. Accurate sequencing not only clarifies the genetic makeup of mermaids but also helps determine how their genomes evolve over time, offering a window into their biological diversity and evolutionary processes.
Comparing Genetic Markers to Known Marine Species
To identify the origin of the mermaid “scales,” researchers compare their genetic markers to those of known marine species. This process helps determine whether the scales come from local fish, invertebrates, or other marine life, providing insight into biodiversity in the area. By matching genetic sequences, you can assess the genetic diversity within marine populations, which is vital for effective marine conservation. Understanding these relationships allows you to track species distribution and potential threats to their habitats. Comparing genetic markers also reveals if the scales originate from common species or rare, protected ones. This step is essential for evaluating the ecological significance of the samples and ensuring that conservation efforts target the right species, ultimately supporting healthier marine ecosystems.
Results: Matches With Marine Fish and Invertebrates
Interestingly, the genetic analysis reveals that many of the mermaid scales closely match known marine fish and invertebrate species. This suggests a surprising level of genetic diversity in the samples, indicating they may originate from multiple sources. However, some results raise concerns about sample contamination, which could influence the accuracy of these matches. The table below highlights the key species identified:
SpeciesMatch ConfidenceAtlantic HerringHighCommon OctopusMediumAtlantic CodHighEuropean SquidLowShrimpMediumThese findings evoke emotion by illustrating the complex web of marine life that could be involved, emphasizing the importance of strict contamination controls in genetic studies.
Significance of Genetic Similarities Detected
The genetic similarities identified in the mermaid scales hold significant implications for understanding marine biodiversity and ecological relationships. These findings challenge the notion that mythological marine creatures lack biological basis, connecting marine mythology with scientific evidence. Recognizing genetic diversity among these samples suggests that what we interpret as mythical may have roots in real, yet undiscovered, marine species or hybrids. The similarities point to shared evolutionary relationships with known fish or invertebrates, highlighting the importance of genetic analysis in revealing hidden biodiversity. This insight helps scientists appreciate the complexity of marine ecosystems and underscores the value of genetic research in uncovering the origins and diversity of species often dismissed as legends.
Insights Into Possible Hybrid or Novel Species
You might notice signs of hybridization or unique genetic markers in the mermaid scales, suggesting the presence of hybrid or new species. These genetic clues point to possible interbreeding events or previously undiscovered species. Exploring these findings could reshape our understanding of mermaid diversity and evolution.
Evidence of HybridizationEvidence of hybridization emerges from DNA barcoding data revealing overlapping genetic markers among different mermaid populations. This hybridization evidence suggests genetic mixing occurs between distinct groups, creating potential hybrid or novel species. Such mixing complicates classification and indicates ongoing evolutionary processes. To better understand this, consider the following:
Hybridization EvidenceGenetic MixingPossible OutcomesOverlapping markersShared DNA segmentsNew hybrid species formInter-species interactionCrossbreeding signalsIncreased genetic diversityAmbiguous classificationBlurred species boundariesEvolutionary implicationsThis table highlights how genetic mixing from hybridization influences mermaid diversity, hinting at complex evolutionary dynamics. Recognizing this evidence helps us appreciate the intricate nature of their genetics and ongoing speciation.
Unique Genetic MarkersUnique genetic markers serve as key indicators of potential hybrid or novel mermaid species by highlighting distinctive DNA sequences not found in known populations. These markers reveal variations in genetic diversity that set certain samples apart from established species. By analyzing these unique sequences, you can gain insights into the evolutionary relationships among different mermaid populations, suggesting possible hybridization events or the existence of previously unidentified species. Such markers help clarify how mermaids have adapted and diverged over time, providing valuable clues about their evolutionary history. Recognizing these distinctive genetic signatures allows researchers to better understand the complexity of mermaid genetics, opening the door to discovering new lineages or hybrid forms that challenge current classifications.
Potential New SpeciesCould these genetic discoveries indicate the presence of hybrid or entirely new mermaid species? It’s a possibility that excites researchers and fuels folklore implications. Some scales show genetic markers unlike any known species, suggesting hybrids between legendary creatures or entirely novel species. These findings challenge traditional views of mermaids as solely mythological, hinting at natural origins or undiscovered diversity. If confirmed, these new species could reshape our understanding of marine life and the stories surrounding them. The potential existence of hybrid mermaids blurs the line between folklore and reality, fueling speculation about their origins. While it’s too early to draw definitive conclusions, the lab results open intriguing questions about the diversity and evolution of these mysterious beings. This research could redefine what we believe about legendary creatures.
Implications for Marine Biodiversity Studies
DNA barcoding of mermaid scales offers a powerful tool for enhancing marine biodiversity studies by enabling precise identification of species that are often difficult to distinguish visually. This technology reveals cryptic diversity, uncovering hidden species that traditional methods might miss. Recognizing this diversity is vital for understanding ecosystem dynamics and species distributions. Accurate identification helps you monitor populations more effectively, informing conservation efforts and protecting vulnerable species. It allows for better assessment of biodiversity hotspots and supports sustainable management practices. By integrating DNA barcoding, you gain deeper insights into the complexity of marine life, ensuring that conservation actions are based on reliable data. Ultimately, this approach strengthens your ability to preserve marine biodiversity in the face of environmental change.
Challenges in Interpreting DNA Barcoding Data
Interpreting DNA barcoding data can be tricky because samples often contain degraded DNA, making it harder to get accurate results. You might also encounter ambiguous matches, which can leave you uncertain about the species identification. These challenges highlight the need for careful analysis and validation when working with barcode data.
DNA Degradation IssuesDespite advances in barcoding techniques, DNA degradation remains a significant challenge when analyzing mermaid “scales,” as damaged genetic material can obscure accurate identification. Degradation often results from poor preservation, exposure to environmental elements, or biological factors, making it harder to get reliable results. You may encounter issues like:
Sample contamination, which can introduce foreign DNA and skew resultsPreservation challenges, leading to fragmented or incomplete DNA samplesDifficulty amplifying degraded DNA during PCR, reducing the chances of successful sequencingThese issues complicate data interpretation and require careful handling and optimized protocols. Overcoming DNA degradation demands meticulous sample collection, storage, and processing to minimize damage and contamination, ensuring more accurate barcoding outcomes.
Ambiguous Genetic MatchesAmbiguous genetic matches often pose a significant hurdle in barcoding mermaid scales, as similar genetic sequences can lead to uncertain species identification. Genetic ambiguity occurs when DNA sequences from different species are too similar to distinguish clearly, making it difficult to assign a definitive identity. This challenge arises because some species share recent common ancestors, resulting in overlapping barcoding regions. When you encounter such ambiguity, it hampers your ability to confidently determine whether the sample belongs to a known species or an unrecognized one. Resolving these uncertainties may require additional genetic markers or more extensive reference databases. Overall, these ambiguous genetic matches highlight the limitations of current barcoding methods and emphasize the need for improved techniques to achieve accurate species identification in complex cases.
Future Research Directions and Technological Advances
Advancements in DNA sequencing technology open exciting opportunities for future research on mermaid scales. These technological advances enable more detailed genetic analysis, helping identify species with greater accuracy and uncovering new insights into their evolutionary history. As you explore this field, you can look forward to breakthroughs like faster sequencing methods, reduced costs, and improved sample preservation techniques. This progress will also facilitate large-scale studies, providing extensive data to clarify myth origins and marine biodiversity. To maximize these opportunities, you should focus on:
Developing portable sequencing devices for fieldworkEnhancing DNA extraction from degraded or tiny samplesIntegrating genomic data with ecological and behavioral researchThese innovations will shape the future of mermaid-related studies and deepen your understanding of marine mysteries.
What These Findings Mean for Myth and Marine Science
These DNA findings profoundly impact how we comprehend both myth and marine science by providing concrete evidence that can clarify long-standing legends and misconceptions. They offer a new perspective on marine folklore, helping distinguish fact from fiction. By validating or debunking myth, scientists can better understand historical accounts and cultural stories. This discovery also encourages a scientific approach to myth validation, integrating folklore with modern technology. The table below highlights key implications:
AspectImpactExampleMyth validationConfirms or refutes legendary claimsMermaid scales and DNA analysisMarine folkloreDeepens understanding of cultural talesLegends vs. scientific evidenceScientific insightAdvances marine biodiversity researchIdentifying unknown speciesPublic perceptionBridges science and storytellingMyth debunking or embracingFuture researchGuides new exploration techniquesDNA barcoding innovationsThis synergy shapes a clearer, evidence-based view of myth and marine science.
Frequently Asked QuestionsCould the Scales Be From a Mythical or Entirely Unknown Species?You wonder if the scales could belong to mythical creatures or an unknown species. While it’s tempting to believe in mythical origins, scientific analysis suggests otherwise. DNA barcoding helps identify species accurately, and current results point to known marine life rather than mythical beings. So, it’s unlikely these scales come from something mythical or entirely unknown, but rather from a real, perhaps rare, marine species that hasn’t been well-documented before.
Are There Ethical Concerns in Collecting and Analyzing Mysterious Marine Samples?Isn’t it tempting to chase the unknown, but you must consider ethical concerns first. When you collect and analyze marine samples, you risk compromising scientific integrity if you don’t follow strict protocols. Sample contamination could lead to false results or harm fragile ecosystems. You have a responsibility to respect marine life, ensuring your research benefits science without disrupting ecosystems or crossing moral boundaries. Ethical practices safeguard both discovery and integrity.
How Do Environmental Factors Influence DNA Preservation in Marine Samples?Environmental factors greatly influence DNA preservation in marine samples. You need to contemplate how temperature, salinity, and exposure to sunlight can cause sample degradation, making DNA harder to analyze. To combat this, you should use effective preservation techniques like freezing or chemical stabilizers immediately after collection. Proper handling minimizes degradation, ensuring you get accurate results from your DNA barcoding efforts and maintain the integrity of the samples for future study.
Can DNA Barcoding Differentiate Between Closely Related or Hybrid Species?Thinking of DNA barcoding as a detective’s magnifying glass, it’s quite effective for species differentiation, even among closely related or hybrid species. You can spot subtle genetic differences that distinguish one species from another, like finding a needle in a haystack. For hybrid identification, it helps reveal mixed genetic traits, confirming whether an individual is a true species or a hybrid. So, yes, DNA barcoding is a powerful tool for these intricate genetic puzzles.
What Are the Limitations of Current DNA Databases for Identifying Rare Marine Organisms?You should know that current DNA databases have limitations like database inaccuracies and taxonomic gaps, which hinder accurate identification of rare marine organisms. These gaps mean some species aren’t yet represented or are misclassified, leading to potential errors. This makes it challenging to rely solely on DNA data for rare species, especially when reference sequences are incomplete or incorrect, reducing confidence in the results.
ConclusionYour journey into DNA barcoding reveals that those mysterious mermaid scales are likely from real marine creatures, not mythical beings. Like uncovering hidden treasures beneath the waves, these genetic clues deepen your understanding of ocean biodiversity. While challenges remain, each discovery lights the way for future research. Ultimately, this blending of myth and science reminds you that the ocean’s secrets are as deep and vast as your curiosity, waiting to be uncovered.
August 12, 2025
How Thermal Drones Revolutionize Night Hunts for Elusive Creatures
Thermal drones revolutionize night hunts by giving you clear heat signatures in low-light conditions, making elusive creatures easier to spot and track. They improve safety and ethics by providing real-time data, minimizing stress on wildlife and reducing invasive methods. These drones boost your efficiency, covering large areas quickly and accurately identifying targets even behind foliage. Advanced thermal tech keeps you ahead in the field. If you keep exploring, you’ll discover how these innovations can further enhance your hunting experience.
Key TakeawaysThermal drones enable clear detection of heat signatures, revealing elusive creatures concealed by camouflage or dense foliage.They provide real-time imaging, improving tracking accuracy and reducing search time during night hunts.Advanced thermal technology allows identification of multiple heat sources, minimizing false alarms and enhancing success rates.Longer flight times and AI integration facilitate efficient, safe, and ethical nocturnal tracking of elusive animals.Multi-spectral capabilities and improved stability expand operational environments, revolutionizing night hunting practices for hard-to-find creatures.Enhancing Visibility in Low-Light Conditions
When searching in low-light conditions, traditional visual tools often fall short, making it hard to spot targets or move safely. That’s where thermal drones come in, offering a clear advantage. Using advanced thermal imaging, these drones detect heat signatures, even through thermal camouflage that might hide creatures from night vision devices. Unlike night vision, which amplifies available light, thermal sensors directly sense heat differences, providing a distinct edge in darkness. This technology allows you to see targets that blend into their surroundings or are concealed by natural cover. With thermal drones, your visibility improves drastically, reducing the risk of missed opportunities or accidents. They turn the darkness into an advantage, giving you confidence to track elusive creatures with precision and safety.
Improving Safety and Ethical Hunting Practices
Utilizing thermal drones can substantially enhance safety and promote ethical hunting practices by providing accurate, real-time data that reduces the need for invasive or disruptive methods. With better visibility, you can identify animals from a safe distance, minimizing stress and disturbance, which supports wildlife conservation efforts. This technology encourages responsible hunting by preventing unnecessary harm and ensuring you target only the intended creatures. Ethical considerations are prioritized when you rely on thermal drones to gather precise location data instead of intrusive tracking techniques. Additionally, thermal imaging helps prevent accidents, protecting both hunters and wildlife in low-light conditions. By integrating this technology, you demonstrate a commitment to sustainable hunting practices that respect animal welfare and uphold conservation principles.
Increasing Tracking Efficiency and Success Rates
Thermal drones substantially boost tracking efficiency and success rates by providing real-time, accurate heat signatures of animals even in dense vegetation or low-light conditions. By analyzing thermal signatures, you can quickly pinpoint elusive creatures without extensive searching. These drones enhance heat signature analysis, allowing you to identify targets faster and with higher precision.
Detect hidden animals behind thick foliageMinimize false alarms with clear heat signature dataCover large areas efficiently in less timeTrack moving targets seamlesslyImprove overall success rates of night huntsThis technology streamlines your tracking process, reducing guesswork and increasing your ability to locate elusive creatures more effectively during night hunts.
Advancements in Thermal Imaging Technology
Recent advancements in thermal imaging technology have dramatically enhanced the capabilities of drones for night hunting. Modern thermal cameras now offer higher resolution and faster processing, making heat signature analysis more precise. This progress allows you to detect even subtle heat differences caused by thermal camouflage, which animals may use to hide from predators or hunters. Improved sensors can differentiate between multiple heat sources, reducing false positives and increasing accuracy. Additionally, innovations like multi-spectral imaging help you analyze heat patterns more effectively, even in complex environments. These technological leaps enable you to identify elusive creatures more reliably at night, overcoming challenges posed by concealment tactics. As thermal imaging continues to evolve, your ability to conduct stealthy, efficient night hunts becomes more sophisticated and successful.
Practical Applications and Future Developments
As thermal drone technology advances, its practical applications in night hunting become increasingly diverse and impactful. You can now use drones equipped with thermal camouflage to blend seamlessly into the environment, making detection more challenging for elusive creatures. Enhanced drone autonomy allows for longer, more precise hunts, reducing the need for manual control. Future developments may include AI-powered thermal analysis, improving target identification and tracking. Additionally, improved flight stability and battery life will enable extended missions in complex terrains. Thermal drones could also integrate with other sensors for multi-spectral imaging, increasing their effectiveness. These innovations will revolutionize night hunts, making them safer, more efficient, and more precise. The future of thermal drones promises exciting advancements for hunters and conservationists alike.
Frequently Asked QuestionsHow Do Thermal Drones Impact Local Wildlife and Ecosystems?Thermal drones can impact local wildlife and ecosystems by causing wildlife disturbance, especially if used frequently or carelessly. Their presence might scare animals, leading to stress or displacement, which can contribute to ecosystem disruption. You should be mindful of their use, avoiding sensitive habitats or times when wildlife is most vulnerable. Responsible operation minimizes negative effects, helping preserve the natural balance and prevent unnecessary disturbance to the environment.
Are Thermal Drones Cost-Effective for Small-Scale Hunters?Did you know that thermal drones can reduce search time by up to 50%? For small-scale hunters, they can be cost-effective if you consider the cost comparison and your budget considerations. While initial investments might seem high, saving time and increasing success rates could make them worthwhile. If you hunt frequently, thermal drones could boost your efficiency without breaking the bank, making them a smart choice for your gear.
What Are Legal Restrictions on Using Thermal Drones for Hunting?You need to check local laws before using thermal drones for hunting. Legal restrictions often include privacy concerns, requiring you to avoid trespassing or invading others’ privacy. Licensing requirements may also apply, meaning you must obtain permits or certifications. Always stay informed about regulations in your area to prevent fines or legal issues. Following these rules guarantees your night hunts remain legal and respectful of others’ rights.
How Do Thermal Drones Perform in Extreme Weather Conditions?You might think thermal drones excel in all weather, but no, they struggle in extreme conditions. Sensor limitations kick in when fog or heavy rain roll in, blinding their thermal vision. Plus, battery performance takes a hit, draining faster than usual in cold or windy weather. So, while they’re great tools, don’t count on them to perform flawlessly when Mother Nature throws a tantrum.
Can Thermal Drones Be Integrated With Other Tracking Technologies?You can definitely integrate thermal drones with other tracking technologies for enhanced efficiency. Infrared imaging allows precise detection even in complete darkness, while sensor integration combines data from GPS, motion sensors, and optical cameras. This synergy helps you track elusive creatures more accurately, adapt to different environments, and improve your overall hunting strategy. By combining these technologies, you maximize your chances of success during night hunts.
ConclusionAs thermal drones transform night hunts, you’ll find yourself spotting elusive creatures more easily and hunting more ethically. The technology’s rapid advancements mean safer, more efficient tracking becomes second nature. Coincidentally, as you embrace these innovations, you’ll also deepen your understanding of wildlife behavior. With every flight, you’re not just improving your success rate—you’re contributing to responsible hunting practices. Embrace this revolution, and discover how thermal drones can redefine your nighttime pursuits.
August 10, 2025
Forensic Tactics to Separate Hoax Photos From Genuine Cryptid Evidence
To separate hoax photos from genuine cryptid evidence, you should analyze metadata and digital footprints for signs of manipulation or tampering. Examine image consistency, shadows, and proportions to spot anomalies or unnatural textures. Use forensic tools to verify image integrity and cross-reference features with known species and habitats. Investigate the source’s credibility and context for motives or bias. Continuing with this approach reveals even more sophisticated techniques to uncover the truth behind cryptid photos.
Key TakeawaysAnalyze metadata, digital signatures, and compression artifacts to detect signs of tampering or digital manipulation.Examine inconsistencies such as mismatched shadows, unnatural textures, or irregular proportions indicating potential hoaxes.Cross-reference the image with known authentic photos and assess environmental or contextual plausibility.Utilize expert forensic tools and peer reviews to identify subtle edits or digital alterations invisible to casual inspection.Evaluate source credibility, eyewitness reliability, and behavioral consistency to distinguish genuine evidence from fabricated images.Analyzing Photo Metadata and Digital Footprints
When examining photo metadata and digital footprints, you can uncover essential clues about a picture’s authenticity. Analyzing digital signatures helps verify if the image has been altered or if it originates from a credible source. By examining metadata, you can identify details like creation dates, device information, and editing history, which can reveal inconsistencies. Assessing image compression is also crucial; excessive compression may indicate manipulation or attempts to conceal editing. If the image shows signs of heavy compression, it might be a sign that details have been erased or altered. These digital footprints serve as vital indicators, helping you determine whether the photo is genuine or potentially fabricated. Paying close attention to metadata and compression details can safeguard your evaluation process from deception.
Examining Image Consistency and Anomalies
Examining image consistency and anomalies is essential for identifying potential hoaxes or genuine cryptid evidence. By understanding the historical context, you can recognize patterns or techniques used in past hoaxes, helping you spot similar tactics today. Cultural influences also shape how images are produced and perceived; certain symbols, styles, or mythic themes may reveal cultural motivations behind a photograph. Look for inconsistencies like mismatched shadows, irregular proportions, or unnatural textures that don’t align with the scene’s context. These anomalies often indicate manipulation or fabrication. Comparing the image with known authentic photos and considering cultural or historical factors can help you assess whether the image is credible or suspicious. Your keen eye for such details is indispensable in separating genuine cryptid evidence from hoax images.
Utilizing Forensic Software for Image Verification
Utilizing forensic software for image verification allows you to uncover subtle signs of manipulation that may not be visible to the naked eye. Deepfake detection tools help identify inconsistencies in pixel patterns, lighting, and facial movements, revealing synthetic or altered images. Watermark analysis is also essential; examining embedded or missing watermarks can indicate tampering or forgery. These software tools analyze metadata, compression artifacts, and other digital footprints that reveal manipulation. By systematically applying these techniques, you can distinguish genuine cryptid photos from hoaxes more effectively. Forensic software offers precise, objective evidence that supports your assessment, reducing reliance on subjective judgment. When combined with other forensic tactics, it becomes a powerful approach to verifying the authenticity of cryptid images.
Cross-Referencing With Known Species and Environments
You should compare the creature in the photo to known species using matching techniques to identify similarities. Checking habitat consistency helps verify if the environment matches where such a species naturally occurs. These steps can quickly reveal whether the evidence aligns with genuine cryptid sightings or is likely a hoax.
Species Matching TechniquesCross-referencing suspect images with known species and their typical environments is a crucial step in forensic analysis of cryptid claims. Focus on scale patterns to identify inconsistencies; genuine animals usually have specific, recognizable arrangements. Examine movement cues as well—how the creature moves can reveal whether it matches known species’ behavior or if it’s artificially fabricated. Look for details like limb articulation, gait, or fluidity of motion, which are difficult to fake convincingly. Comparing these elements with documented behaviors and physical features helps you spot hoaxes or misidentifications. If the scale patterns don’t align with a known species or the movement cues seem unnatural or exaggerated, it raises suspicion. This technique sharpens your ability to distinguish authentic cryptid evidence from manipulated or staged images.
Habitat Consistency ChecksHabitat consistency checks involve comparing the environment depicted in a cryptid image with the known habitats of similar species to identify discrepancies. You examine whether the location aligns with the known geographical distribution of related animals, considering factors like climate, terrain, and ecological impact. If an image shows a creature in a habitat inconsistent with its supposed species’ range, it raises suspicion. For example, a cryptid claimed to live in dense forests should not appear in arid deserts or high-altitude regions unless there’s evidence of ecological adaptability. Cross-referencing known environments helps verify authenticity by ensuring the habitat matches the species’ ecological impact and geographical distribution. Discrepancies often indicate hoaxes or misrepresentations, making habitat consistency a crucial forensic check.
Investigating Source Credibility and Context
You need to assess how trustworthy the photo source is before drawing conclusions. Using contextual analysis techniques helps you understand the circumstances surrounding the image, while cross-verification methods confirm its authenticity. By carefully evaluating source reliability and context, you can better distinguish genuine cryptid evidence from hoaxes.
Source Reliability AssessmentEvaluating the credibility of a source is essential when distinguishing genuine cryptid evidence from hoaxes. Begin with historical document analysis to verify the origin and authenticity of reports or images. Check for consistency over time and cross-reference with other credible sources. Eyewitness testimony evaluation is also fundamental; consider the witness’s background, potential biases, and the conditions under which they reported sightings. Look for signs of embellishment or inconsistency that may indicate fabrication. Avoid relying solely on a single account; instead, seek corroboration from multiple, independent sources. This rigorous assessment helps you determine whether the evidence is likely genuine or manipulated, ensuring that your conclusions are based on reliable, well-vetted information.
Contextual Analysis TechniquesTo accurately assess the credibility of cryptid evidence, it’s essential to analyze the context surrounding each source. Consider photographic ethics—whether the image was manipulated or staged—and how cultural symbolism might influence its interpretation. Understanding the origin of the photo helps reveal motives or potential biases that shape its presentation. Cultural symbolism can also color how images are perceived; for example, certain symbols or settings may be intentionally included to evoke specific beliefs or emotions. By examining these factors, you gain insight into the authenticity of the evidence beyond surface-level analysis. Contextual analysis helps differentiate genuine cryptid sightings from hoaxes rooted in cultural narratives or ethical lapses in photography, strengthening your overall assessment.
Cross-Verification MethodsCross-verification involves scrutinizing the credibility of sources and the context in which cryptid evidence appears. You need to assess whether psychological deception influences the presentation or interpretation of the evidence, as hoaxes often exploit biases or mislead viewers. Consider cultural influences that shape how cryptids are perceived or reported; understanding local legends, folklore, and societal beliefs helps distinguish genuine sightings from fabricated claims. Verify the source’s history and motives—are they known for hoaxes or credible investigations? Cross-referencing multiple independent reports and analyzing the consistency of details can reveal patterns indicative of authenticity or deception. By critically examining source credibility and context, you minimize the risk of falling for psychological deception and better identify genuine cryptid evidence.
Applying Expert Analysis and Peer Review
Expert analysis and peer review are essential steps in distinguishing authentic cryptid evidence from hoaxes. You rely on specialists to evaluate the evidence objectively, often using artificial intelligence tools to detect subtle manipulations. Expert consensus helps validate findings and weed out false positives. During peer review, multiple experts scrutinize the evidence, ensuring rigorous standards are met.
StepPurposeExpert AnalysisDetects signs of digital tampering or artificial editsPeer ReviewConfirms findings through multiple independent assessmentsArtificial IntelligenceAssists in identifying inconsistencies and deepfakesThis process ensures that only credible evidence contributes to cryptid research, reducing the influence of hoaxes.
Frequently Asked QuestionsHow Can Deepfake Technology Impact Cryptid Photo Authenticity?Deepfake technology can seriously challenge your ability to verify cryptid photos’ authenticity. As deepfake detection improves, you’ll need to stay alert for manipulated images that look convincing but are false. This tech complicates distinguishing genuine cryptid evidence from hoaxes, making image authenticity harder to assess. To counter this, focus on forensic analysis methods that identify inconsistencies and artifacts, helping you separate real evidence from sophisticated digital fabrications.
What Role Do Eyewitness Testimonies Play in Validating Images?You rely on eyewitness testimonies to validate cryptid images, but their credibility matters. Strong eyewitness accounts often enhance image authenticity, especially when testimonial consistency is confirmed over time. You should evaluate whether the witness is reliable and if their story remains consistent across different recountings. While valuable, testimonies alone aren’t foolproof; combining them with forensic analysis helps you better distinguish genuine cryptid evidence from hoaxes.
Can AI Detect Subtle Manipulations in Cryptid Photographs?Like Sherlock Holmes unraveling a mystery, you wonder if AI can spot subtle manipulations in cryptid photographs. Using advanced photo forensics, AI analyzes details that humans might miss, evaluating image authenticity with precision. It detects inconsistencies, shadows, or pixel anomalies, helping distinguish genuine evidence from hoaxes. With this technology, you gain a powerful tool to validate cryptid images, moving closer to uncovering the truth behind elusive creatures.
How Does Cultural Bias Influence Photo Interpretation?You should consider how cultural perceptions shape your interpretation of cryptid photos, making it easier to see what confirms your beliefs and dismiss what doesn’t. Media influence often reinforces these biases, leading you to accept certain images as real or hoax based on popular narratives. Being aware of this bias helps you analyze photos more objectively, focusing on evidence rather than cultural stereotypes or media-driven expectations.
Are There Legal Considerations in Sharing Suspicious Cryptid Images?Did you know over 60% of people share suspicious images online without considering legal ramifications? When you share cryptid images, legal ramifications and privacy concerns come into play, especially if the photo invades someone’s privacy or is part of a hoax. You must be cautious, as sharing misleading or unverified images could lead to legal trouble, damage reputations, or violate privacy laws, putting you at risk of serious consequences.
ConclusionBy mastering these forensic tactics, you become a detective in the epic quest for truth, slicing through hoaxes like a hot knife through butter. Your keen eye and thorough analysis can reveal the tiniest inconsistencies hiding in plain sight, turning the tide against false cryptid claims. Remember, in this world of shadows and illusions, your diligence is the ultimate weapon—because uncovering reality is the most vital puzzle you’ll ever solve.



